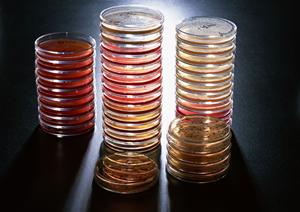
有名な大阪のクリニックで乳房再建治療

医療についての記事一覧
-
- 2025年最新版:尼崎で信頼できる消化器内科を選ぶための完全ガイド
-
尼崎市内で消化器内科をお探しの方にとって、信頼できる診療所やクリニックを見つけることは健康維持において重要な課題です。消化器内科は...

-
- 福岡市東区の歯医者完全ガイド2026:選び方とおすすめクリニック【最新情報】
-
福岡市東区において、信頼できる歯医者をお探しの方にとって、良質な歯科医療サービスを提供する医院を見つけることは非常に重要です。家族...

-
- 品川で選ばれる小児科クリニック徹底ガイド【2024年最新版】
-
品川エリアで子供の健康管理に関して信頼できる小児科をお探しの親御さんにとって、適切な医療機関の選択は非常に重要です。子供の体調不良...

-
- 鹿児島市で乳腺の健康を守る!最新の診断と治療法を徹底解説【2026年最新版】
-
鹿児島市内には、乳腺に関する健康診断や検査を受けられる医療機関が充実しています。特に乳腺検査は、乳がんの早期発見に不可欠な検査の一...

-
- 2025年最新|福山で評判の良い眼科を徹底比較!満足度の高い医療サービスを選ぶポイント
-
福山地方において信頼性の高い眼科をお探しの方には、地域密着型で患者さん一人ひとりの目の健康を丁寧にサポートする医療機関があります。...
-
- 東郷町の内科おすすめランキング2026|最新情報と選び方のポイント
-
東郷町に住む多くの方々にとって、信頼できる内科医を見つけることは、家族の健康を守るために欠かせない重要なポイントです。地域の内科ク...

-
- 守山市で選ばれる歯医者を徹底解剖!2025年最新の治療法と安心のサポート
-
守山市で信頼できる歯医者を探す際に、多くの方が重視するポイントは、痛みの少ない治療や予防ケアの充実、子供連れでも安心して通える環境...
-
- 小倉北区の信頼できる歯医者トップガイド2025年最新情報
-
小倉北区で信頼できる歯医者を探している方にとって、安心して通える歯科医院を見つけることは重要です。特に家族全員の口腔ケアを一箇所で...

-
- 葛飾区で信頼できる高血圧専門医を見つけるための最新ガイド【2025年版】
-
葛飾区で高血圧に関する診療を受けたいと考える方にとって、信頼できる高血圧専門医の存在は非常に重要です。高血圧は自覚症状がなくても進...
-
- 茂原市で叶える理想の白い歯!2025年最新ホワイトニング完全ガイド
-
茂原市でホワイトニングを検討されている方々にとって、自分の歯の白さや健康的な笑顔は重要な関心事です。最近では、多くの人が短時間で効...
-
- 【2025年最新】松戸市の循環器内科で最も信頼できるクリニック徹底ガイド
-
松戸市において循環器内科をお探しの方にとって、信頼できる医療機関の選択はとても重要です。特に高齢者や心血管疾患のリスクが高い方にと...

-
- 板橋区の矯正歯科選びに役立つ最新ガイド【2025年版】
-
板橋区には、多くの矯正歯科クリニックが点在しており、患者さんのニーズに応じた多彩な治療を提供しています。特に、地元で信頼されている...

-
- 南大阪で安心のインプラント治療を実現!最新技術と信頼の医療を徹底解説
-
南大阪エリアでのインプラント治療を検討している方にとって、信頼性の高い歯科医院の選択は非常に重要です。失った歯を補うための最適な方...

-
- 小児皮膚科の選び方と浜松で信頼できるクリニックを徹底解説【2025年最新情報】
-
浜松において信頼できる小児皮膚科を探す親御さんにとって、どの医療機関を選ぶかは子供の健康管理において非常に重要なポイントです。子供...

-
- 大田区の小児科徹底ガイド2025年版:安心できるクリニック選びと最新の子ども医療情報
-
大田区は東京都の南部に位置し、都心からもアクセスが良く、住宅地や商業施設が充実している地域です。特に子育て世帯にとっては、安心して...
-
- 最新2025年版!石神井エリアで受ける経鼻内視鏡の安心と信頼のガイド
-
石神井エリアで経鼻内視鏡検査を受けたいと考える方にとって、痛みや不快感の少ない検査方法を選ぶことは非常に重要です。経鼻内視鏡は、伝...

-
- 最新2025年版:港北区で選ぶべき歯医者トップガイドとその特徴
-
港北区で歯医者をお探しの方にとって、信頼できる歯科医院選びは大切なポイントです。現代の医療サービスは、安心感と利便性を重視しながら...
-
- 吹田市の歯医者選びを成功させる!2025年最新ガイドで見つかる理想の歯科医院
-
吹田市には、多くの歯医者が点在しており、その中から信頼できる歯科医院を見つけることは、家族の健康維持や自分自身の美しい笑顔を保つた...

-
- 【2025年最新版】世田谷区で評判の良い歯医者トップ10|選び方と通院のポイント
-
世田谷区で信頼できる歯医者を探す際、多くの方がまず重視するポイントは、アクセスの良さや診療時間、子供連れでも安心して通えるかどうか...

-
- 春日井市で信頼できる内科クリニックを見つけるには?選び方とおすすめポイント
-
春日井市には、地域の皆さんが気軽に訪れることができる信頼できる内科クリニックが数多く存在しています。忙しい日常の中で、健康管理やち...

-
- 【2025年最新版】久留米市の歯医者徹底ガイド|失敗しない歯科医院選びのポイント
-
久留米市で歯医者を探す際、多くの方が重視するポイントは、信頼できる医師の存在や通いやすさ、そして子どもも安心して任せられる環境です...

-
- 【2025年最新版】芦屋市で実践できる糖尿病対策の最前線ガイド
-
芦屋市で糖尿病の管理や予防に関心を持つ方にとって、信頼できる医療機関や適切な治療法を見つけることは非常に重要です。糖尿病は適切な管...

-
- 2025年最新版:飯田市の歯医者選びに役立つ完全ガイド
-
飯田市で信頼できる歯医者を探す際には、多くの方が地域密着型の医療機関を重視します。家族全員が安心して通える歯科医院を見つけることは...
-
- 2025年最新!歯科のおすすめ対策と選び方完全ガイド
-
健康的な笑顔と快適な生活を送るためには、定期的な歯科の受診が欠かせません。しかし、どの歯科が最も信頼できて、自分にとって最適なのか...

-
- 福岡の訪問介護を成功させるための完全ガイド【2025年最新版】
-
福岡で訪問介護のサービスを検討している方にとって、信頼できる支援体制や適切なサービス内容を理解することは非常に重要です。高齢者やそ...

-
- おおたかの森で選ばれる歯医者トップガイド【2025年最新情報】
-
おおたかの森エリアで信頼できる歯医者を探している方にとって、便利さと安心感は非常に重要なポイントです。おおたかの森は、都心からのア...

-
- 北千住で評判の歯医者を徹底比較!2025年最新版の選び方とおすすめポイント
-
北千住エリアで信頼できる歯医者をお探しの方にとって、どの医院を選ぶかは非常に重要なポイントです。地域密着型の歯科医療を提供し、患者...
-
- 【2025年最新】川崎で受けるICL手術の全て|安全性と費用を徹底解説
-
川崎でICL手術を検討している方にとって、視力回復の選択肢として注目すべき方法の一つが眼内コンタクトレンズ、すなわちICL手術です...
-
- 五反田で安心して通える心療内科の選び方と治療法ガイド
-
五反田には多くの心療内科が存在し、ストレスや不安、うつ病などのメンタルヘルスに関する問題に悩む人々にとって、非常に重要な役割を担っ...
-
- 【2025年最新】金沢文庫で評判の内科医院ベストガイド:選び方とおすすめポイント
-
金沢文庫に位置する内科クリニックは、地域の皆さまの健康を支える重要な存在です。このエリアで内科をお探しの際には、信頼できる医師と丁...
.jpg)
-
- 2025年最新版:新宿区で評判の精神科クリニックを徹底比較!安心と信頼の医療を探すための完全ガイド
-
新宿区において精神科を受診することは、精神的な健康を維持し、生活の質を向上させるために非常に重要です。特に忙しい都市生活の中で、ス...

-
- 2025年最新!鹿児島中央駅周辺で選ばれる歯医者トップガイド
-
鹿児島中央駅周辺には、多くの歯医者が点在していますが、その中でも信頼できる医療機関を選ぶことは非常に重要です。駅からアクセスの良さ...

-
- 2025年最新!循環器内科の効果的な対策と最前線の治療法
-
循環器内科は、心臓や血管の疾患に関する専門医療を提供する診療科であり、健康維持や生活の質の向上を目指す方々にとって重要な役割を果た...

-
- 東京で受けられるがん検診を贈り物に!健康を気遣う特別なギフトの選び方ガイド
-
東京において、がん検診は健康管理のための重要な要素です。定期的ながん検診を受けることで、早期発見や早期治療が可能になり、重篤な病気...

-
- 大津市で内視鏡検査を安心・安全に受けるための完全ガイド【2025年最新情報】
-
大津市内で内視鏡検査を受けることを検討している方にとって、信頼できる医療機関を見つけることは非常に重要です。特に、消化器系の健康維...
-
- 目立たない・痛みの少ない大人の歯の矯正を実現!信頼できる歯医者選びと最新治療法の完全ガイド
-
歯の矯正は、多くの大人や子供にとって、歯並びや咬み合わせの改善を目的とした重要な治療です。美しい口元や健康的な歯列を手に入れるため...

-
- 静岡市で人気のホワイトニングサービス徹底ガイド!自宅でできる美白法やクリニックの選び方とは
-
静岡市の住民にとって、ホワイトニングは美しい笑顔を手に入れるための効果的な方法です。特に最近では、見た目の印象が大切にされる場面が...

-
- 【2025年最新】箱崎エリアで評判の歯科医院徹底比較!選び方と通院のポイント
-
箱崎に位置する歯科医院をお探しの方にとって、信頼できる歯科医院選びは非常に重要です。地域密着型の安心できる歯科を求めている方々にと...

-
- 足立区で見つける信頼の高血圧専門医|安心して相談できるクリニックと治療法
-
足立区において高血圧の治療や管理を専門に行う医師を探している方にとって、信頼できる高血圧専門医を見つけることは非常に重要です。高血...

-
- 高津区の内科事情を徹底解説!最新2025年版の信頼できるクリニックガイド
-
高津区内科の医療施設は、地域の健康維持や生活習慣病の予防において非常に重要な役割を果たしています。特に中高年層を中心に、定期的な健...

-
- 練馬区で評判の良い皮膚科おすすめ一覧|子供から美容まで信頼できるクリニック紹介
-
練馬区には、多くの皮膚科クリニックが点在しており、その中から信頼できる医療機関を選ぶことは、肌の悩みを解決するために非常に重要です...
-
- 【2025年最新版】世田谷区で信頼できる産婦人科を見つけるための完全ガイド
-
世田谷区で信頼できる産婦人科を探す際には、適切な情報収集と医療機関の選択が非常に重要です。世田谷区は都心からのアクセスも良く、多く...
-
- 安心して通える台東区の婦人科:女性の健康と出産を支える信頼の医療情報
-
台東区は東京都の中心部に位置し、歴史的な街並みと現代的な都市景観が調和する地域です。このエリアには多くの女性が安心して通える婦人科...

-
- 安心と実績の地域密着型インプラント治療|群馬で選ばれる信頼の歯科医院ガイド
-
群馬県内でインプラント治療を検討している方々にとって、信頼できる歯科医院の選択は非常に重要です。特に、見た目の自然さや噛みやすさ、...

-
- 安心と信頼の歯科ケアを提供!宮前区で評判の歯医者を徹底比較
-
宮前区において、信頼できる歯医者をお探しの方にとって、地域に根ざした高品質な歯科医療を提供する医院選びは重要なポイントです。宮前区...
-
- 京都で見つける!目立たない矯正治療のメリットとおすすめクリニックガイド
-
京都で目立たない矯正治療を受けることは、見た目を気にする多くの方にとって魅力的な選択肢です。特に、仕事やプライベートでのコミュニケ...

-
- 島田市の眼科事情を徹底解説!2025年最新の選び方とおすすめクリニック
-
島田市にある眼科医院は、地域の皆様の眼の健康を守る重要な拠点として高い信頼を集めています。眼科の専門医師が常駐し、視力検査や目の不...

-
- 三宮で信頼できる矯正歯科を徹底解説!見た目と健康を両立させる最適な選び方
-
三宮エリアで矯正治療を検討している方にとって、信頼できる矯正専門のクリニック選びは非常に重要です。特に、忙しい生活の中で通いやすさ...

-
- 【最新情報】五反田の美容皮膚科で叶える理想の素肌ケアと信頼の施術選び
-
五反田は都心からのアクセスが良く、気軽に立ち寄れる美容皮膚科が充実している地域として、多くの女性から注目されています。肌の若返りや...

-
- 子どもの歯の健康を守る!久我山の小児歯科で安心・安全な予防ケアと治療を実現
-
久我山の小児歯科は、子どもの歯の健康維持にとって重要な役割を果たしています。子どもたちの歯は、大人に比べて治癒力が弱く、むし歯や歯...
-
- 忙しいあなたの味方!池袋で見つかる信頼の胃腸科クリニックと最適な健康管理法
-
池袋周辺で胃腸科をお探しの方にとって、信頼できるクリニックの選択は健康維持において非常に重要です。特に忙しい日々を送る中で、胃の不...
-
- 板橋エリアで選ばれる!子ども連れと女性に優しい歯科医院の特徴と最新医療のポイント
-
板橋エリアには、多くの歯科医院が存在し、その中から自分や家族に最適な歯科を見つけることは容易ではありません。特に子どもや女性に優し...

-
- 中之島で選ばれる歯医者の秘密|信頼と安心の歯科医院を見つける方法
-
中之島において信頼できる歯医者を探す際、多くの方が重視するポイントは、丁寧でわかりやすい説明、家族みんなで通える環境、そして安全性...
-
- 【2024年最新版】名古屋市南区で選ばれる歯医者のポイントと安心の治療環境
-
名古屋市南区で信頼できる歯医者を探す場合、地域の特徴やアクセスの良さ、安全性、そして患者一人ひとりに寄り添った丁寧な治療体制を重視...
-
- 安心して通える!渋谷の信頼できる心療内科の選び方とおすすめポイント
-
渋谷は東京都心の中心地として、多くの人々が訪れる繁華街であり、ビジネスマンだけでなく若者や観光客など多彩な層が集まるエリアです。そ...

-
- 豊島区で理想の歯並びを実現!家族に優しい矯正治療の選び方ガイド
-
豊島区における矯正治療は、子どもから大人まで幅広い年齢層に対応した重要な医療サービスです。矯正治療は、歯並びや咬み合わせの改善を目...
-
- 人間ドックのギフト券を贈る理由とおすすめプラン完全ガイド
-
人間ドックを受けることは、健康管理において非常に重要なステップです。特に、近年の忙しい生活の中で、定期的な健康診断が必要であること...
-
- 新宿エリアで選ぶ!忙しい方も簡単に受けられる健康診断の最新ガイド
-
新宿は都心の中でも特にアクセスが良く、多くの人が日常的に訪れるエリアです。そのため、健康診断を受けたいと考える方にとって、便利で信...
-
- 京橋で叶える自然な白さと効果を実感できるホワイトニングのすべて
-
京橋エリアでホワイトニングを検討している方にとって、自然な白さと快適な施術を両立させることは重要なポイントです。多くの人が求めるの...

-
- 「さいたま市で信頼できる心療内科を見つけるための完全ガイド」
-
心の健康は、私たちの生活において非常に重要な要素です。特に現代社会では、ストレスや不安、うつ病などのメンタルヘルスに関する問題が増...

-
- 「東長崎矯正の魅力と信頼の理由:家族に優しい歯科医院を徹底解剖!」
-
東長崎矯正は、子供から大人まで幅広い年齢層に対応した矯正歯科医院として、多くの患者さんに信頼されています。特に子供の歯並びに関する...
-
- 港区で信頼できる児童精神科クリニック徹底ガイド|子どもの心のケアと安心の医療体制
-
港区において子どものメンタルヘルスに関心を持つ親御さんにとって、信頼できる児童精神科を見つけることは非常に重要な課題です。子どもは...

-
- 東大阪市で信頼できる整形外科の選び方と最新医療情報
-
東大阪市には、多くの整形外科クリニックが点在しており、地域の皆様が気軽に利用できる医療機関が充実しています。特に、膝や腰の痛み、関...
-
- 千葉で選ぶ!自分にぴったりの補聴器専門店ガイドと最新テクノロジーのご紹介
-
聴力の低下は、多くの人々にとって日常生活に影響を及ぼす深刻な悩みとなります。特に高齢者においては、会話の際に聞き取りづらさを感じる...
-
- 両国エリアで評判の歯医者を徹底比較!安心して通える歯科医院の選び方と最新治療法
-
両国エリアで信頼できる歯医者を探す際、多くの患者さんは安心して通えるクリニックを重視します。両国は歴史と文化が息づく街でありながら...

-
- 地域密着型!阪神西宮で評判の整形外科クリニックと選ばれる理由
-
阪神西宮エリアで信頼できる整形外科をお探しの方にとって、地域に根ざした専門的なケアを提供するクリニック選びは非常に重要です。阪神西...
-
- 世田谷区で選ぶ!目立たず快適なマウスピース矯正の全貌とおすすめクリニックガイド
-
近年、歯の矯正治療において注目を集めているのがマウスピース矯正です。特に世田谷区では、目立たず、快適に歯並びを整えることができるた...

-
- 梅田で見つける!あなたに最適なメンタルクリニックの選び方とおすすめ一覧
-
梅田には多くのメンタルクリニックが存在しており、精神的な健康をサポートする役割を果たしています。ストレスや不安、うつ病などの悩みを...
-
- 東京で安心して通えるメンタルクリニック徹底ガイド:自分に合ったサポートを見つける方法
-
東京には多くのメンタルクリニックが存在しており、心の健康を維持するための専門的なサポートを提供しています。ストレスや不安、うつ病な...

-
- 品川区で信頼できる呼吸器科クリニックを見つけるための完全ガイド
-
品川区において呼吸器科の専門クリニックを探す際には、地域のアクセスの良さや医師の専門性、信頼性が重要なポイントとなります。呼吸器科...

-
- 人間ドックを贈る理由と選び方ガイド:大切な人への特別なギフト券活用法
-
人間ドックは、健康管理の重要な一環として多くの人々に利用されています。特に、定期的な健康診断を受けることが推奨されている中で、より...
-
- 中央林間で見つかる!糖尿病予防と管理に役立つ最適な医療・健康サポートガイド
-
中央林間は、多くの方にとって住みやすい街として知られ、その一方で地域の医療環境も充実しています。特に糖尿病の予防や治療に関心を持つ...

-
- 金沢市で選ばれる歯医者ベストガイド|安心・丁寧な治療と地域密着の歯科医院紹介
-
金沢市には多くの歯科医院が点在しており、家族全員が安心して通える歯医者を選ぶことは、健康な歯を維持するために非常に重要です。特にお...

-
- 仙台で叶える快適な睡眠:睡眠障害の原因と効果的な対策方法を徹底解説
-
仙台市内に住む多くの人々が、慢性的な眠りの問題に悩まされています。特に、睡眠障害は生活の質を著しく低下させ、日常の活動や仕事に支障...
-
- 板橋で信頼できる歯科医院を見つける!最新設備と子連れに優しい安心の歯科ガイド
-
板橋区には、多くの歯科医院が存在し、それぞれが患者のニーズに応えるために様々なサービスを提供しています。特に家族で通える歯科や、予...

-
- 信頼と実績のサクラギクリニック:米子市で選ばれる内科医のポイント
-
米子市で内科をお探しの方にとって、信頼できる医療機関を見つけることは健康維持の第一歩です。米子市内には、地域の皆様の健康を支える内...

-
- 熊本で選ばれる産婦人科の秘密:安心と信頼の医療環境と最新治療法
-
熊本における産婦人科選びは、妊娠や出産を控える多くの女性にとって非常に重要なポイントです。信頼できる医師や充実した設備、安心して相...

-
- つくば駅周辺で評判の良い歯医者を徹底紹介:安心の定期検診と親子で通える医院選び
-
つくば駅周辺には数多くの歯医者が点在しており、地域の住民や働く人々にとって身近な存在となっています。特に、つくば駅から徒歩圏内の歯...

-
- 川崎での糖尿病対策完全ガイド:早期発見から生活習慣改善まで知っておくべきポイント
-
川崎市における糖尿病は、地域の健康問題として非常に重要なテーマです。糖尿病は、体内のインスリンの分泌や作用に異常が生じることによっ...
-
- 「京都で見つける!目立たない矯正治療のすべてと美しさを保つ秘訣」
-
美しい景観と豊かな歴史を誇る京都は、多くの人々が訪れる魅力的な場所です。しかし、ここに住む人々や観光客の中には、見た目の美しさに気...
-
- 横須賀中央で安心・安全なインプラント治療を受けるための完全ガイド
-
近年、歯科治療の選択肢が多様化する中で、インプラント治療は特に注目を集めています。この治療法は、失った歯を人工の歯根を用いて再び機...

-
- 大山駅周辺で評判の良い内科を徹底解説!信頼できる医師と快適な健康管理のポイント
-
大山駅の周辺には、地域の皆さんの健康を支える信頼できる内科医療機関が数多く点在しています。特に、日常的な健康管理や生活習慣病の予防...
-
- 岐阜市で安心してピル処方を受けるためのクリニック完全ガイド
-
岐阜市でピル処方を受けたいと考える女性にとって、選択肢と情報が豊富にあることは重要です。ピルは避妊方法として広く利用されており、正...
-
- 小牧市で安心・安全なインプラント治療を受けるための完全ガイド
-
インプラント治療は、失った歯を補うための効果的な方法として、多くの人々に選ばれています。小牧市に住む方々にとっても、インプラントは...

-
- 豊島区での子どものための矯正治療ガイド:安全で安心な歯科医院選びのポイント
-
豊島区において矯正治療を検討する際、まずは適切な歯科医院の選択が重要です。近年、矯正治療はただの美容目的だけでなく、口腔の健康や機...

-
- 山形市で評判の整形外科おすすめランキング|信頼できる診療所と最新治療法の完全ガイド
-
山形市において整形外科を選ぶ際には、多くの方が正確な診断と適切な治療を提供してくれる医療機関を求めています。高齢化が進む中、関節や...

-
- 世田谷で信頼できる内科クリニックを選ぶポイントと最新の医療情報
-
世田谷区は、都心からのアクセスの良さと閑静な住宅街が調和する魅力的な地域です。そんな地域において、健康維持や日常の体調管理において...
-
- 新富町で見つけた!家族も安心して通える痛みの少ない歯医者ガイド
-
新富町には、地域に根ざした優れた歯医者が多く存在し、患者のニーズに応じた多彩な治療メニューを提供しています。特に、この町で評判の良...

-
- 「家族で通える!溝の口の信頼できる歯医者ガイドと最新治療法」
-
溝の口エリアには、信頼性の高い歯医者が多数存在し、地域の住民に健康的な口腔環境を提供しています。歯科医療は、単に虫歯の治療だけでは...
-
- 小岩で家族全員の歯の健康を守る!信頼できる歯医者の選び方ガイド
-
小岩における歯医者選びは、家族の健康を守るために非常に重要です。特に、子供の虫歯予防や痛みの少ない治療を提供する歯科医院は、多くの...
-
- 北九州で見つける!うつ病克服のための心強いサポートとリソースガイド
-
北九州におけるうつ病は、地域のメンタルヘルスに関する重要なテーマです。この地域では、うつ病に苦しむ人々が数多く存在し、適切な治療と...
-
- 都筑区で整体を受けるメリットとは?肩こり・腰痛改善に最適な施術ガイド
-
都筑区には多くの整体院が存在し、日々の疲れや体の不調を和らげるために多くの人々に利用されています。整体は、筋肉や関節の調整を通じて...

-
- 新宿でおすすめの循環器内科クリニックガイド:健康管理をサポートする専門医の選び方
-
新宿は東京の中心に位置し、多くの医療機関が集まっています。その中でも特に注目されるのが循環器内科です。心臓や血管に関する専門的な診...

-
- 大分市で心の健康を守る!おすすめの心療内科とその活用法ガイド
-
大分市にお住まいの方々が心の健康を維持するために、心療内科への受診は重要な選択肢となります。心療内科は、ストレスや不安、うつ病など...

-
- 品川区の心療内科を徹底解説!ストレス軽減に最適な専門機関の選び方
-
心療内科は、ストレスや不安、精神的な症状に悩む人々にとって、心の健康を保つための重要な存在です。特に品川区では、様々な心療内科があ...

-
- 秋葉原で見つける理想の歯科クリニック!痛みの少ない治療法と最新設備の全貌
-
秋葉原は、オタク文化の中心地として知られていますが、最近ではその周辺で高品質な歯科医療を受けられるクリニックも増加しています。特に...
-
- 関内で探す!信頼できる精神科クリニックの選び方と治療の流れ
-
関内地域における精神科の医療機関は、心の健康をサポートするために重要な役割を果たしています。現在、精神的なストレスや不安を抱える人...
-
- 阿佐ヶ谷で安心・快適に通える歯医者ガイド:家族の健康を守るための選び方とポイント
-
阿佐ヶ谷は東京の中でも落ち着いた雰囲気を持つエリアで、多くの人々が住む地域です。この周辺には、家族の健康を守るための信頼できる歯医...

-
- 港北区で信頼できる皮膚科を探す!ニキビやシミ改善のための完全ガイド
-
港北区において皮膚科を探す際、さまざまな選択肢がありますが、信頼できる医療機関を見つけることが重要です。皮膚科は、肌に関する様々な...
-
- 「五反田駅周辺でおすすめの心療内科!メンタルヘルスをサポートするクリニック一覧」
-
心療内科は、ストレスやメンタルヘルスの問題に対処するための専門的な医療機関です。特に、繁忙な日常を送る方々にとって、心療内科の存在...
-
- 練馬区の消化器内科での診療内容と内視鏡検査のメリットを徹底解説!家族の健康を守るための情報ガイド
-
練馬区にお住まいの方々にとって、消化器内科は胃腸の不調や生活習慣病の管理において重要な役割を果たします。消化器内科は、胃や腸、肝臓...
-
- 木更津で見つける最適な補聴器選びのポイントとアフターサポートガイド
-
木更津における補聴器の選択は、聴覚に悩む多くの人々にとって重要な課題です。聴力の低下は、日常生活やコミュニケーションに大きな影響を...

-
- 福岡市でおすすめの脳神経外科:健康管理と専門治療を受けるための完全ガイド
-
脳神経外科は、人間の神経系に関連する病気や障害に対処する専門分野であり、その診療は非常に重要です。特に福岡市においては、近年この分...
-
- 家族の健康を守る!板橋で信頼できる内科医を見つけるための完全ガイド
-
板橋地域において、内科医を探すことは、家族の健康管理や病気予防において非常に重要な課題です。特に、小さなお子様を持つ家庭では、子供...
-
- 京都での歯科矯正治療を徹底解説!信頼できるクリニックと最新の治療法ガイド
-
歯科矯正は、美しい笑顔を手に入れるための有効な手段として、多くの人々にとって関心の高いテーマです。特に京都においては、歴史的な背景...

-
- 西大寺で安心して受けられるインプラント治療の全貌とおすすめ歯科医院ガイド
-
西大寺にお住まいの方々や、インプラント治療を検討している方には、信頼できる歯科医院選びが非常に重要です。インプラント治療は、失った...
-
- 「矯正歯科治療の選び方と疑問解消ガイド:理想の歯並びを手に入れるためのステップ」
-
矯正歯科は、歯並びや噛み合わせの改善を目指す治療法として、多くの人々に支持されています。美しい歯並びは、見た目の印象だけでなく、口...

-
- 薬院エリアで人気の歯医者を徹底比較!口コミ評判から選ぶおすすめ歯科医院
-
薬院で歯医者をお探しの方にとって、適切な歯科医院を見つけるためには、信頼性や技術力など様々な要素を考慮する必要があります。薬院エリ...
-
- 台東区での内視鏡検査を安心して受けるための完全ガイド:痛み軽減と迅速な結果説明を実現する方法
-
台東区における内視鏡検査は、多くの人々にとって重要な健康管理の一環です。この地域は、医療施設が充実しており、専門性の高い医療サービ...

-
- 豊洲で見つける!子供に優しい小児歯科医院の選び方とおすすめクリニックガイド
-
豊洲で子供たちの歯の健康を守るために、小児歯科は非常に重要な役割を果たしています。特に子供の成長期において、正しい歯のケアと定期的...

-
- 生野区で家族の健康を守る!内科クリニックの選び方と診療内容ガイド
-
生野区に住む方々にとって、健康管理は非常に重要なテーマです。特に内科に関しては、多くの人々が定期的な健康診断や病気の予防・治療に関...
-
- 羽沢横浜国大周辺で選ぶ信頼できる歯医者の見つけ方とインプラント治療のポイント
-
羽沢横浜国大周辺での歯医者選びは、多くの人々にとって重要なテーマです。特に、健康や口腔ケアに対する関心が高まる中、信頼できる医療機...
-
- 札幌で痛みの少ないホワイトニングを受ける方法を徹底解説!
-
札幌で歯のホワイトニングを考えている方にとって、効果的かつ安心して施術を受けられる歯科クリニックの選び方は重要です。札幌市内には多...
-
- 歯の美しさと健康を手に入れる!札幌市中央区で人気のホワイトニングサロンを徹底解説
-
歯の美しさを追求する方々にとって、歯のホワイトニングは魅力的な選択肢です。札幌市中央区にお住まいの方やお勤めの方が、より美しい笑顔...

-
- 町田での内視鏡検査を徹底解説!信頼できるクリニック選びと最新技術のご紹介
-
内視鏡検査は消化器系の疾患を早期発見・診断するために非常に重要な検査です。特に町田地域では、医療機関が増えているため、信頼できるク...

-
- 大阪市中央区で内視鏡検査を受ける前に知っておきたい重要ポイントとおすすめクリニックガイド
-
内視鏡検査は、消化器系の異常を早期に発見するために非常に重要な手段です。特に大阪市中央区に住む方々にとって、健康診断やがん検診の一...

-
- 浜松でおすすめの小児皮膚科を徹底比較!診療内容と予約方法を詳しく解説
-
浜松で小児皮膚科をお探しの方にとって、子供の皮膚の健康を守るために専門的な診療を受けることは非常に重要です。子供の皮膚は大人と比べ...

-
- 家族全員で通える!痛みの少ない「抜かない歯医者」の選び方完全ガイド
-
抜かない歯医者という概念は、近年注目を集めています。多くの人々が歯科治療に対して抱く恐怖心や不安感を軽減するため、抜かずに治療を行...
-
- 大牟田市で子供の歯を守る!通いやすく信頼できる歯科クリニックの選び方ガイド
-
大牟田市にお住まいの方々にとって、歯科の選び方は非常に重要なテーマです。特に家族全員の口腔健康を考えると、信頼できる歯科医院を見つ...
-
- 「循環器内科の重要性と最新治療法:健康維持のために知っておくべきすべて」
-
循環器内科は心臓や血管に関連する疾患の診断と治療を専門とする医療分野であり、多くの病気がこの領域に属しています。心筋梗塞や心不全、...
-
- 博多で選ばれる矯正歯科の全貌!信頼できる医院と治療法を徹底解説
-
博多で矯正歯科を考える際、まず重要なのは自分に合った治療法と信頼できる医院を見つけることです。歯並びを整えることは、見た目の美しさ...

-
- 小平市で家族全員が通える安心の歯医者選びガイド【予防歯科・子供のケアもバッチリ】
-
小平市にお住まいの皆さんにとって、信頼できる歯医者を見つけることは非常に重要な課題です。家族全員が通える歯科医院を探す際には、ただ...
-
- 家族全員が安心して通える歯科医院の選び方とおすすめポイントガイド
-
家族全員の健康を支えるためには、信頼できる歯科医院を見つけることが重要です。特に小さな子供を持つ家庭では、定期的な歯科検診が欠かせ...

-
- 家族の健康を守る!海老江エリアでおすすめの信頼できる歯医者ガイド
-
家族の健康を守るためには、定期的な歯科検診が欠かせません。特に、子どもたちの虫歯予防は、早期の対策が重要です。海老江エリアには、家...
-
- 白金台で評判の良い歯医者を徹底比較!家族全員の健康を守るために知っておきたいポイント
-
白金台における歯医者選びは、家族全員の健康を守るために非常に重要です。このエリアには、信頼できる歯科医院が数多く存在し、それぞれが...

-
- 自然な仕上がりと簡単な取り扱い!医療用ウィッグの魅力とカラーバリエーションを徹底解説
-
近年、医療用ウィッグの需要が増加しています。医療用ウィッグは、様々な理由で自然な髪の毛を失った方々にとって、外見や自信を取り戻すた...
-
- 熊本で見つける理想の矯正歯科:子供から大人まで安心の治療ガイド
-
熊本には多くの矯正歯科が存在し、家族の健康や美しい笑顔を手に入れるための選択肢が豊富に揃っています。矯正治療は、歯並びを整えるだけ...

-
- 妊婦健診のプロが教える!品川地域で安心・安全な妊娠・出産をサポートするノウハウ
-
妊娠中の女性にとって、健康管理は非常に重要です。その中でも特に重要なのが妊婦健診です。妊婦健診は、妊娠中の母体や胎児の健康を確認す...

-
- 快適さとおしゃれを両立!介護服選びのポイントとおすすめ商品ガイド
-
介護服は、介護を受ける方にとって不可欠なアイテムです。特に高齢者になると、身体的な変化や健康状態によって、着る服の選び方が重要にな...
-
- 歯並びの改善ならこちら!浜松市で最新治療技術を取り入れた矯正歯科医院を徹底比較
-
浜松市で矯正治療をお考えの方にとって、通いやすい場所にある歯科医院を見つけることは重要です。浜松市内には、矯正治療を専門とする歯科...
-
- 松阪市の歯医者ならここ!インプラント治療もお任せください
-
松阪市にお住まいでインプラント治療を考えている方にとって、信頼できる歯医者を見つけることは非常に重要です。松阪市には数多くの歯医者...
-
- 川崎でのICL手術完全ガイド:近視改善のための最前線情報と信頼できる眼科の選び方
-
視力の改善を求める多くの人々にとって、目の健康は重要な関心事です。特に近視に悩む方々にとって、最新の医療技術であるICL手術は、期...
-
- 釧路市で家族みんなが安心して通える歯医者ガイド:子供の健康を守るためのポイントと診療スタイルの紹介
-
釧路市において、家族全員が通える歯医者をお探しの方には、事前に知っておきたい情報が多くあります。まず、釧路市内には多くの歯科医院が...

-
- 船橋で見つける!安心・効果的な医療脱毛クリニック完全ガイド
-
船橋で医療脱毛を受けることを考えている方にとって、安全で効果的な施術を行うクリニック選びは非常に重要です。医療脱毛は、美容目的だけ...

-
- 東大阪市の脳神経外科ガイド:症状別の専門医選びと最新治療法を徹底解説
-
東大阪市には、脳神経外科の専門的な診療を行う医療機関が多く、地域の住民にとって頼れる存在となっています。脳神経外科は、脳や脊髄、神...

-
- 家族全員が通いやすい!箕面のおすすめ歯科医院ガイド
-
箕面での歯科医療は、家族全員の健康を守るために重要な要素です。特に、子供の虫歯予防や成人の歯周病対策が求められており、地域に根ざし...

-
- ストーマ装具の選び方と使い方:安心して生活するための完全ガイド
-
ストーマ装具は、ストーマを持つ方々にとって不可欠なアイテムであり、その選び方や使用方法は個々の生活の質に大きな影響を与えます。スト...
-
- 歯科治療の安心と信頼を体感!地元密着の高崎歯科でのインプラント治療をご紹介
-
歯の欠損や不安定さでお悩みの方にとって、[高崎]でインプラント治療を受けることは、自信を取り戻し笑顔を取り戻す大きな一歩となります...

-
- つくばで受けられる循環器内科の専門診療とは?健康維持のための完全ガイド
-
つくば市において循環器内科の重要性は増しており、特に心臓病や高血圧などの循環器疾患が増加しています。このため、地域の医療機関におけ...

-
- 函館市での大腸カメラ検査ガイド|安心して受けるための流れとポイント解説
-
函館市における大腸カメラ検査は、健康維持やがん検診の一環として非常に重要な役割を果たしています。特に40代以降の方々にとって、大腸...
-
- 岩槻で家族全員が通いやすい歯医者を見つけるための完全ガイド
-
家族の健康を守るために、優れた歯医者を見つけることは非常に重要です。特に子供の歯並びや虫歯予防を考えると、信頼できる歯医者選びは欠...

-
- 「京都で見つける!子供と大人のための矯正歯科ガイドと費用の全貌」
-
近年、矯正歯科の需要が高まる中、京都でも多くの矯正歯科医院が存在しています。特に子供の歯並びに対する関心は高く、早期の矯正治療を検...

-
- 歯科インプラント治療の費用と保障について詳しく解説します
-
歯のインプラント治療は、歯の補綴方法として人気が高まっています。札幌でインプラント治療を考えている方にとって、信頼性や安心感は非常...
-
- 鹿島田で家族全員が通いやすい歯医者を探すための完全ガイド
-
鹿島田には、地域住民の健康を支える歯医者が多く存在し、それぞれが独自のサービスを提供しています。特に、家族全員が通いやすいクリニッ...

-
- 歯医者が多い天神エリアでの虫歯予防について徹底解説
-
歯のトラブルでお困りの方が、天神エリアで信頼できる歯医者をお探しの際には、専門性の高い治療と温かいサービスを提供する歯医者が重要で...

-
- 板橋区の耳鼻科で家族の健康を守る!最適なクリニック選びと治療法ガイド
-
板橋区には多くの耳鼻科が存在しており、地域の方々にとって信頼できる医療機関が数多くあります。耳鼻科は、聴覚や嗅覚、さらには喉の健康...
-
- 「祐天寺で信頼できる歯医者を見つけるための完全ガイド – 健康な口腔環境を手に入れる方法」
-
祐天寺には、信頼できる歯科医院が多数存在し、地域住民の口腔健康を支える重要な役割を果たしています。歯科医師の選択は、患者の健康に直...

-
- ペースメーカーを持つ方向けの東京の病院
-
心拍数が何らかの疾患により低下してしまう状態を改善する器具が、ペースメーカーです。東京都江東区にある、「なないろハートクリニック」...

-
- 歯の美しさを手に入れる!効果的な練馬のホワイトニング方法をご紹介
-
練馬で歯のホワイトニングを考えている方にとって、効果的な方法や注意点を知ることは重要です。歯のホワイトニングは、歯の美しさを取り戻...

-
- 静岡での無痛分娩のすべて:安心安全なお産のための完全ガイド
-
妊娠や出産に関する選択肢が多様化している現代において、無痛分娩は多くの女性にとって注目される選択肢となっています。静岡では、無痛分...

-
- 橋本で予防歯科をお探しならここがお勧め
-
予防歯科とは、ブラッシングの指導やフッ素コーティング等で虫歯や歯周病にならないための予防的な処置のことを言います。歯は生きていくう...

-
- 仙台であがり症改善!効果的な対策方法を徹底解説
-
仙台であがり症の改善方法について知りたい方へ。あがり症は、人前で話すことに対する恐怖心や緊張感が原因で、日常生活や仕事でのコミュニ...

-
- 家族全員が安心して通える歯医者選びのポイントとおすすめ治療法ガイド
-
歯医者は私たちの健康において非常に重要な存在です。口腔内の健康は全身の健康に影響を与えるため、定期的な歯科検診や適切な治療が欠かせ...
-
- 江戸川区で信頼できる女医がいる産婦人科の選び方とおすすめ病院ガイド
-
妊娠や出産、女性の健康に関心を持つ方々にとって、信頼できる産婦人科を見つけることは非常に重要です。特に、江戸川区に住んでいる方や近...

-
- 枚方市での泌尿器科受診ガイド:症状別診断から便利な予約方法まで徹底解説
-
枚方市にお住まいの方々にとって、泌尿器科に関する情報は非常に重要です。泌尿器科は尿路系の病気や症状に特化した医療分野であり、男性や...
-
- 名古屋で受けるインプラント治療の全貌!安全性と信頼性を徹底解説
-
名古屋におけるインプラント治療は、近年多くの人々にとって注目を集めています。インプラント治療は、失った歯を補うための効果的な方法で...

-
- 神戸で話題の再生医療技術を解説!最新美容ケアの秘密に迫る
-
神戸で注目される再生医療についてご紹介します。再生医療は、自身の細胞を活用して疾患や障害を治療する革新的な医療技術であり、神戸市内...

-
- 歯の健康と美容を両立!京橋の歯医者が提供する最高レベルの治療とサービス
-
歯の健康を保つためには、定期的な歯科検診が欠かせません。しかし、歯医者選びにおいては、信頼できる歯科医院を見つけることが重要です。...

-
- 静岡市で注目の矯正治療を徹底解説!
-
歯並びの改善を考える際、静岡市で矯正治療を受けることは、多くの方々が検討する選択肢の一つです。静岡市には様々な歯科医院が存在し、そ...
-
- 京都で子供の矯正に強い歯科医院
-
歯並びの悪さはコンプレックスにもつながりますし、健康面での悪影響が出る心配もあります。最近は、大人世代になってから矯正治療を始める...

-
- 目黒区で通いやすいマウスピース矯正クリニックを徹底比較!探していた方におすすめの場所はここです!
-
目黒区や世田谷区に通いやすい場所にある矯正歯科クリニックを探している方にとって、マウスピース矯正は非常に魅力的な選択肢となっていま...
-
- 整形外科クリニックの選び方|座間市で評判の高い医療機関を徹底比較
-
座間市にお住まいの方や近隣地域から整形外科をお探しの方々に向けて、整形外科クリニックの選び方や特長についてご紹介します。座間市には...
-
- 歯の美容と健康を守る!江戸川区の歯医者が提供する最新の歯科治療とは?
-
江戸川区にお住まいの方々にとって、歯医者選びは重要な課題です。歯の健康を維持するためには、信頼できる歯医者を見つけることが大切です...
-
- 鹿児島市で安心の消化器内科クリニックを見つけるポイント
-
鹿児島市にお住まいの方で、消化器に関する健康管理を考えている方に向けた情報をご紹介します。消化器内科は消化器系の疾患に特化した診療...
-
- 東戸塚エリアの評判歯医者を徹底比較!口コミや設備、料金まで徹底解説
-
歯の健康に気を配る方にとって、信頼できる歯医者を見つけることは重要です。東戸塚エリアで評判の良い歯医者を探している方には、安心して...
-
- 歯科治療の最新トレンドを知る!今福鶴見の歯医者選びのポイント
-
歯科医院を選ぶ際には、信頼性と安心感が最も重要です。その中で、今福鶴見に位置する歯科医院は、地域の方々に支持される理由があります。...

-
- 歯周病予防に効果的!正しいブラッシング方法とは?
-
余戸地区にお住まいの方々や近隣にお住まいの方々にとって、予防歯科は重要な健康管理の一環と言えます。予防歯科は、虫歯や歯周病を未然に...

-
- 更年期に関する症状と対策を徹底解説!
-
更年期には、体調の変化や悩みがつきものですが、尼崎市周辺で適切なサポートを受けることで、この時期を快適に乗り越えることができます。...
-
- 日本橋エリアの内科医院で健康相談を受ける方法とポイント
-
日本橋にある内科医院は、都心で忙しいOLの方々にとって身近な存在です。健康管理や病気予防のために、定期的な内科健診や急な体調不良時...

-
- 奈良市で子供向けのやさしい歯医者を見つけるポイント
-
奈良市にお住まいの方や周辺地域で歯医者をお探しの方にとって、信頼できる歯医者を見つけることはとても重要です。奈良市には多くの歯医者...
-
- 脂肪吸引の安全性と効果を徹底解説!【最新技術】
-
脂肪吸引は、脂肪を取り除くことで理想のボディラインを手に入れるための施術方法です。悩みの解消や自信回復につながる一方で、安全性やア...

-
- 虎ノ門周辺の歯医者を徹底比較!選び方のポイントと口コミ評判を解説
-
虎ノ門周辺で信頼できる歯医者を見つけることは、歯の健康を維持する上で重要です。歯のトラブルは日常生活に支障をきたすこともありますが...

-
- 自然な笑顔を取り戻す方法を南大阪の方々へご紹介
-
歯科医療技術の進化により、歯を失った際に選択肢が広がったのが「インプラント治療」です。南大阪エリアでも、多くの歯科医院がインプラン...

-
- 歯科医師が解説!インプラント治療のメリットと堺で受けられる最高のサービス
-
歯のインプラント治療を考えている方にとって、信頼できる歯科医院を見つけることは非常に重要です。堺市にお住まいの方におすすめのインプ...
-
- 錦糸町の歯医者がおすすめする!歯の矯正、虫歯治療、ホワイトニングのポイント
-
歯のトラブルでお悩みの方にとって、信頼できる歯医者を見つけることは非常に重要です。錦糸町には多くの歯医者がありますが、自分に合った...

-
- 安心・信頼の東京で受けられる人工中絶手術のポイント【最新情報】
-
東京で安心して人工中絶手術を受けるためには、信頼できるクリニックを見つけることが重要です。人工中絶手術は、患者のプライバシーや安全...

-
- 恵比寿エリアで安心のペインクリニックを徹底比較!適切な治療法を見つけよう
-
恵比寿にあるペインクリニックは、痛みに悩む方々にとって心強い存在です。痛みの原因を明らかにし、適切な治療を提供することで、患者の生...

-
- 渋谷エリアでセラミック治療を受けるメリットと注意点-専門家が解説
-
渋谷エリアでセラミック治療を受ける際には、信頼できる歯科医院の選択が重要です。セラミック治療は、自然な見た目と耐久性を兼ね備えてお...
-
- 歯の美白と歯並びの改善を叶える!選び抜かれた文京区の矯正歯科医院特集
-
歯並びの悩みを抱える方にとって、矯正歯科治療は重要な選択肢です。特に東京都文京区にお住まいの方は、身近な場所で通いやすい歯科医院を...

-
- 熊本の産婦人科での不妊治療について知る:専門知識と安心のカウンセリング
-
妊娠を希望している方や不妊治療を考えている方にとって、信頼できる産婦人科医院を見つけることは非常に重要です。熊本市北区にある北くま...

-
- 勝どきエリアで夜間診療可能な耳鼻科クリニックを徹底比較
-
東京湾に面した勝どきは、多くのオフィスワーカーや住民が利用するエリアであり、健康管理の一環として耳鼻科の専門家による診察を求める声...
-
- 歯の健康と見た目を両立!名古屋駅近くの矯正歯科で効率的な治療を始めよう
-
名古屋駅周辺で矯正歯科をお探しの方におすすめの情報をご紹介します。名古屋駅は、交通アクセスが良く、診療所や歯医者が多数点在していま...

-
- 女性の健康をサポートする田町の優良産婦人科をご紹介!
-
田町にある産婦人科を検索する人々にとって、信頼できる医療機関を見つけることは非常に重要です。産婦人科は妊娠、出産、女性の健康に関わ...

-
- 歯医者が教える!天神エリアで人気の歯科治療法とは?
-
歯医者をお探しの方にとって、信頼できる歯科医院を見つけることは非常に重要です。福岡の中心地である天神には、多くの歯医者が存在してい...

-
- 熊本市北区の産婦人科医院「北くまもと井上産婦人科」の特徴と診療内容を徹底解説
-
熊本市北区に位置する「北くまもと井上産婦人科医院」は、地域の産婦人科医療を担う重要な存在です。産婦人科医院選びは妊娠中や出産後の女...
-
- 腎機能と健康について知る:山形市内の泌尿器科・内科クリニックを徹底解説
-
腎機能は、体内で非常に重要な役割を果たす臓器の一つです。その中でも、山形市内で信頼できる泌尿器科・内科クリニックを見つけることが重...

-
- 京都で不妊治療を考える方へ。おすすめ医療機関と最新情報をご紹介
-
京都で不妊治療をお考えの方におすすめの医療機関をご紹介します。京都は歴史と文化が息づく美しい街であり、不妊治療を受ける際にも落ち着...
-
- 流山市で選ぶ!信頼できる矯正歯科医院のポイントとは?
-
流山市で矯正歯科治療を受ける際、信頼性や通いやすさは非常に重要です。流山市内には多くの歯医者がありますが、矯正歯科治療を受けるため...

-
- 堺市の矯正歯科で痛みの少ない治療を受けて美しい笑顔を手に入れよう!
-
歯並びの改善を考える際に、堺市で矯正歯科をお探しの方におすすめのポイントをご紹介します。堺市には多くの歯科医院がありますが、矯正治...
-
- 内科の専門医が診る西宮の医療機関!信頼性とアクセスの良さを徹底解説!
-
西宮市で内科の診療を受ける際には、信頼できる医療機関を選ぶことが重要です。内科は一般的な病気や慢性疾患の診療を担当しており、私たち...

-
- 三宮エリアで人気の矯正歯科クリニックを徹底比較!
-
歯並びの改善を考える際、三宮にある矯正歯科クリニックをご検討中の方に向けて、矯正治療に関する重要な情報をお届けします。三宮に位置す...
-
- 心斎橋エリアの最高の歯医者を見つける方法完全ガイド
-
心斎橋エリアで信頼できる歯医者を探している方々に向けて、おすすめの歯医者についてご紹介します。心斎橋は、多くのオフィスワーカーや主...

-
- 歯並びの悩みを解消!宇都宮の矯正歯科で理想の笑顔を手に入れよう
-
宇都宮にある矯正歯科クリニックをご検討中の方に向けて、矯正治療に関する重要な情報をお届けします。宇都宮市内には多くの矯正歯科クリニ...

-
- 日本橋の美容に特化した皮膚科クリニック
-
日本橋にある皮膚科で、治療や美容相談をするなら日本橋形成外科・皮フ科・美容外科が最適です。わきが治療は保険が適用になりますので経済...

-
- ツムラの当帰芍薬散の通販が人気
-
西洋ではなく、自然な生薬で体の調子を整えたい方の間で漢方薬が人気を集めています。漢方薬は体に合っていれば西洋薬と同じかそれ以上に効...
-
- 千葉で注目されている不妊症の治療
-
千葉に住んでいる方に朗報です。もし不妊症で悩んでいるようでしたら、鎌ヶ谷アートクリニックで相談してみましょう。こちらのクリニックは...

-
- 循環器科クリニックの選び方とポイントを解説!
-
板橋区にある循環器科をお探しの方々へ、循環器系の健康管理や専門的な診療についての重要性についてお伝えします。板橋区には多くの循環器...
-
- 堺東駅周辺で通いやすい歯医者を見つける!【完全ガイド】
-
歯の健康を守るためには、定期的な歯科健診や適切な治療が不可欠です。堺市に位置する堺東駅周辺には、多くの歯医者が存在し、患者のニーズ...
-
- 甲状腺と東京で専門医の診療を受けたい方必見!虎の門小澤クリニックのアクセス方法と診療時間をご紹介します
-
甲状腺の疾患や治療に関心を持つ東京在住の方々にとって、信頼できる専門医や情報を見つけることは重要です。今回は、東京で甲状腺に特化し...

-
- ニキビ治療のプロが教える!大阪で効果的なニキビ対策方法とは?
-
ニキビ治療に関して、大阪で信頼できる医療機関を探している方々への情報提供を目指し、以下におすすめのニキビ治療方法と大阪で評判の良い...
-
- 新宿の循環器内科で健康診断を受ける方法を徹底解説
-
心臓や血管に関する病気や健康管理を専門とする「循環器内科」は、健康に関心の高い方にとって重要な診療科目です。特に新宿エリアにお住ま...
-
- 表参道の最先端!歯科技術を駆使した歯医者の魅力を徹底解説
-
表参道にある歯医者をお探しの方にとって、信頼性や充実したサービスが重要なポイントとなります。歯の健康を維持するためには、定期的な歯...

-
- 京都でおすすめの泌尿器科を徹底解説!
-
京都で泌尿器科をお探しの方におすすめの医療機関をご紹介します。泌尿器科は、尿路や前立腺などに関するトラブルを専門に診療する科であり...

-
- 歯の健康を守る信頼できる歯医者が豊橋に!【完全ガイド】
-
豊橋市で信頼できる歯医者をお探しの方へ、歯の健康に関する重要な情報をご紹介します。歯のトラブルは日常生活に支障をきたすことがありま...

-
- 高品質で手ごろな価格の医療用かつら
-
「アンベリール」は、病気などで毛髪が失われてしまった時に装着する、医療用かつらの通販・レンタルを行うショップです。自然な質感の医療...

-
- 郡山市の歯医者選びのポイントとは?専門家が解説
-
郡山市にお住まいの方や周辺地域から通院される方にとって、歯医者選びは重要なテーマです。歯の健康や美しさを保つためには、信頼できる歯...

-
- 白山の産婦人科で叶える安心と信頼の妊娠・出産サポート
-
白山にある産婦人科で女性の健康をサポートする重要性について考えてみましょう。産婦人科は、妊娠や出産だけでなく、更年期障害や女性特有...

-
- 効果的な脱毛を提供するジェントルマックスプロの大阪クリニックを徹底解説!
-
脱毛を考えている方にとって、安全かつ効果的な施術を受けることは非常に重要です。その中でも、ジェントルマックスプロという脱毛機器を使...
-
- 東京で安心・プライバシー重視の中絶手術を受けるなら必見!
-
東京で中絶を希望する方にとって、安心して手術を受けられる医療機関の選定は非常に重要です。東京都内には多くの産婦人科がありますが、中...

-
- 歯科治療の革命!最新テクノロジーを駆使した効率的な歯科インプラント治療とは?
-
インプラント治療は、歯科医療の分野で最も革新的な治療法の一つとして注目されています。歯を失った際に、天然の歯に近い見た目と機能を取...
-
- 目立たないマウスピース矯正で世田谷区の魅力的な笑顔を手に入れよう!
-
世田谷区でマウスピース矯正をお考えの方へ、おすすめの治療方法についてご紹介します。マウスピース矯正は、目立たない矯正方法として人気...

-
- インビザラインが可能な五反田の歯科
-
矯正治療で大きな問題点としてあげられるのが、滑舌が悪くなるという点です。これは、歯並びを改善するための装置が口の中に当たってしまっ...
-
- 家族揃って安心!予防歯科に特化した和歌山市の歯医者を徹底解説
-
和歌山市にお住まいの方や周辺から通院を考えている方にとって、信頼できる歯医者を見つけることは重要です。歯の健康は家族全員にとって欠...

-
- 北新地エリアで高評価の歯医者を徹底比較!口コミ人気の歯科医院を一挙公開
-
歯の健康管理は日常生活において欠かせない要素です。その中でも、歯医者選びは重要なポイントの一つです。特に、北新地エリアで信頼できる...

-
- カルテのチェック機能を使う利点
-
レセプトを作成する際にミスが多発してしまい、患者からの信頼を失った経験がある医療関係者からも、東京メディコムのサービスは注目されて...
-
- 歯医者選びで重要なポイント!桶川市の歯科クリニックを徹底比較
-
桶川市にお住まいの皆さんにとって、歯科医院の選択は重要な健康上の決断です。歯の健康は全身の健康と深く関連しており、定期的な歯科検診...
-
- 港区で優れた産婦人科を探すポイントを解説!信頼できる医療機関を見つける方法
-
妊娠中や出産予定の女性にとって、信頼できる産婦人科医院を見つけることは非常に重要です。特に港区にお住まいの方々にとっては、近隣の産...
-
- 戸田駅の歯医者でお口の悩みを改善
-
戸田駅周辺でお口の健康にお悩みの方々へ、心地よい歯科治療を提供するために戸田駅の歯医者は患者様を第一に考えています。当院では患者様...
-
- 広尾で安心のインプラント治療!歯の健康と美しさを叶える最高の選択肢
-
広尾でインプラント治療をお考えの方へ。インプラント治療は、歯を失った場合の最も効果的な対策の一つです。広尾地域で信頼性の高いインプ...
-
- 銀座では精神科によって得意不得意がある
-
これにより疾患の早期発見と、丁寧な医学処置の開始が可能となり治療タームや回復期間を短縮することができます。メンタル診療に、おいては...

-
- 郡山の歯医者でインプラント治療を受ける
-
郡山の歯科医院は2000年に開業をしてから、地域に密着した歯科診療を行っています。大切な歯を失ってしまったら、義歯で補う必要がある...

-
- 自分の好きな時間に通える博多の歯科
-
美容や健康のことを考えて、博多のこの歯科を利用する人はとても多いです。特に、口周りの美意識を改善していくことでより美しい状態にする...
.jpg)
-
- 産婦人科京都の専門クリニックで安心の不妊治療を受ける方法
-
産婦人科専門のクリニックを検索する際、多くの女性が信頼性と安心感を求めています。その中でも、「京都,産婦人科」で検索する方々は、不...

-
- しっかり大和市の歯科医を調べよう
-
早期の診断と、措置により病状の進行を抑えることができます。大和市の歯医者で予防と早期医学処置の肝要性は、クリニックを長期的に受診す...

-
- 本駒込の歯科の選択で地域別の評判
-
本駒込で大きな一括払いを、避け治療を受けやすくなります。一部の地域では歯の学校での手当が提供されており学生が、指導のもとで患者をア...

-
- 大阪で内視鏡下手術の快適さと速い回復
-
大阪の病院で継続的な教育は医師や医療従業員は、継続的な医学教育を受けるチャンスを設けます。最近の療法知識やテクノロジーに、追随し依...

-
- 痛みの少ない治療が可能な山口市の歯医者
-
山口市にあるこちらの歯医者は様々な技術を取り入れており、痛みに配慮した治療も行っています。麻酔を適切に使用するというだけでなく、麻...

-
- 椎名町で注目されている治療とは
-
遊び場所にはおもちゃや絵本DVDなどが、備えられていることが多く、小学生たちは楽しく遊んでいるうちに診療時間を待つこと、が出来ます...
.jpg)
-
- シェアNo.1企業の電子カルテシステム
-
東京メディコムホールディングス株式会社では、医療機器のICT・システム化の情報運搬人としての役割を持ち、電子カルテシステムやレセプ...
-
- 港区の内科で間質性肺炎の治療をうける
-
間質性肺炎は、肺の間質と呼ばれる組織に炎症や瘢痕が生じる肺の疾患です。ILDは進行性の病気であり、徐々に肺の組織が破壊され、瘢痕組...
-
- 梅田にある精神科で受診をしたい
-
梅田にある心療内科・精神科の「大阪メンタルクリニック」は、大阪駅・梅田駅にほど近いのでアクセスが良いのが特徴です。診察は常時複数の...
-
- 蒲田エリアで人気の高い歯科クリニック
-
大田区蒲田の「はらだ歯科クリニック」では、可能な限り天然の歯を残せるような根管治療に注力しており、マイクロスコープや歯科用CTを導...

-
- 上大岡のクリニックで新生児の栄養指導
-
新生児の栄養指導は非常に重要であり、新しい生命を健康に育てるために欠かせない要素です。新生児は生まれたばかりで免疫力が低いため、正...

-
- 西宮市で整形外科を探したいならば
-
西宮市で整形外科を探す際、電話予約とネット予約は便利な選択肢です。どちらが適しているかを考える前に、それぞれの魅力について詳しく見...

-
- 沼津の歯科医院で歯の健康維持に努めよう
-
人間は毎日のように食べ物を咀嚼しないといけないので、口の中の歯や歯茎には相当な負担がかかっています。特に砂糖がたっぷり含まれた食べ...

-
- 3つの路線で便利!駅近くの歯医者
-
高齢になっても自分の歯を残す8020運動が浸透した現在では、予防歯科が重視されるようになりました。高齢になると増える痴呆症を予防す...

-
- 金沢市で独自の施術が人気の接骨院
-
石川県金沢市にあるこの接骨院では、スポーツの怪我から交通事故のむち打ち治療、猫背・姿勢矯正など、幅広い施術を行っています。骨折・脱...

-
- 吹田で内視鏡検査に強い医療機関
-
胃腸の具合が悪くその原因がはっきりしない場合は、内視鏡検査でより精密な検査をすることもあります。こうした検査をすることで、外からは...

-
- 清水区の歯科治療はどこでも同じ?
-
清水区の歯科医院が措置の需要に応じて機器を増減させる必須があるケース月の貸出し契約を見直すことで容易に対応することが出来ます。小児...
-
- 港区の心療内科でうつ病を相談する
-
港区しろかねたかなわクリニック心療内科は、うつ病やストレス関連障害などの心の健康に関する診療を専門としています。うつ病は誰にでも起...

-
- 初台で健康診断を受けることの重要性
-
健康診断は健康を維持し、疾患を早期に発見するために非常に重要な役割を果たしています。これは生活において欠かすことのできないプロセス...

-
- 内科医をきちんと大林町で把握しよう
-
大林町の内科で決済い方法はメンタル診断は通常現金クレジットカードデビットカード電子マネーなどさまざまな支払い方法を受け付けていると...

-
- 綾瀬で高血圧の症状をチェックできる
-
自分自身は健康だと思っていても、実際には病気が隠れている事も多くあります。普段から健康的な生活を心がけるだけでなく、定期的に検査を...

-
- 福島に歯科医院はたくさんある傾向
-
現行のテクノロジーや手法を取り入れている医師は、より効果的な施術を与えることができます。価格の安いインプラントで依頼者自身も歯科医...
-
- 新居浜の訪問看護ステーションひなた
-
愛媛県新居浜市の訪問看護ステーションひなたは、訪問看護サービスを提供しています。病気や障害を抱えている方の中には、入院するよりも家...

-
- 介護士求人にも有利となる主婦のスキル
-
これから住吉区で長年主婦業をしていたけれども、介護業界に飛び込みたいと考えている人も多いかもしれません。実は介護現場においては主婦...

-
- 芦屋市内で審美歯科といえばこちら!
-
見た目の美しさにも気を遣った歯の噛み合わせのための治療を受けたいけれど、どこに行けばそのような理想的な治療を受けられるのかがわから...
-
- 朝霞台の眼科で緑内障日帰り手術
-
緑内障日帰り手術は、近年の医療技術の進歩により、患者が同日に手術を受けて帰宅することができる便益があります。この手術は主に眼の中の...

-
- 札幌の不安のないインプラント治療
-
札幌市で診療に当たっているこちらの歯科クリニックでは、インプラント治療を専門に行っています。これまで2000本以上の治療実績があり...
-
- 銀座で内科治療の品質を求めるなら
-
銀座の心療内科でこれは、療法旅行や海外からの紹介国際的な診断協力などが背景にあることがあります。精神科病院の世界シェアは、診療分野...
-
- 緑内障の原因と治療方法を知ろう
-
眼の病気にも色々な種類がありますが、特に緑内障は気をつけたい病気です。これは、視野が少しずつ欠けていき、見える範囲が狭くなる病気で...
-
- インプラント治療なら安佐南が最適
-
美しく均整のとれた歯並びをしていると、それだけで顔全体に清潔感が生まれて綺麗に見えることがあると思います。しかしながら、日本人の多...

-
- 白金で良い内科医を選定するコツ
-
一般的に、担当によって措置方針が異なるケースが存在します。措置の効果や副作用に、ついての知見が十分に提供されていない場合もあります...

-
- 新栄でおすすめできる小児歯科とは?
-
子供の健康を守ることは親としての一つの務めでもあるため、少しでも痛がる様子を見せたり口臭が気になる場合には早めに治療をすすめること...

-
- 心療内科なら小倉区のここが安心です
-
ストレス社会といわれている現代は多くの人が、職場や学校や対人関係などで悩みや心の病を抱えたりストレスを抱えているものです。そんな時...

-
- 栄の痛みへの配慮を施した歯科医院
-
虫歯や歯周病の状態を改善したいと考えている人にとって、最小限の負担で終えられるこの歯医者の治療はとても魅力的です。今まで歯医者に対...
-
- 東京の甲状腺専門医によるクリニック
-
東京虎ノ門病院から徒歩5分、そして虎ノ門のJRや地下鉄各駅から歩いて約5分という利便性の高い立地にある虎ノ門小澤クリニックです。当...

-
- 矯正治療も行う春日部駅近くの歯科
-
埼玉県春日部市にあるラビット歯科は、東武伊勢崎線と東武野田線の春日部駅西口から歩いて4分ほどの場所にある人気の歯医者です。診療は木...

-
- 練馬区で歯科医院の数は増え続けている
-
お年寄りでも丁寧なアシストと、管理を行うことで人工歯手術の成功率を向上させることが出来ます。最近アプリケーションに、伴い練馬区のイ...
-
- 八幡西区で内視鏡検査を受けるなら
-
硬水でマグネシウムが豊富なミネラルウォーターをたくさん飲んで不溶性食物繊維も積極的に摂って便量を増やし排便を促進、腸で生きる力が強...
-
- 大阪で大腸カメラをするならここ
-
大阪堺市の「医潤会内視鏡クリニック」は、内視鏡専門のクリニックです。こちらでは、数多くの症例を経験してきた内視鏡専門の医師による検...

-
- 白金で実力のある内科医を選ぼう
-
具体的な改善方法について以下に示します。白金の心療内科の措置は、個人のすこやかさやオフィス状況に合わせて調整されるため効果的であり...
.jpg)
-
- 新型出生前診断ができる東京のクリニック
-
こちらのクリニックは、丁寧できめ細やかなサポートが特徴の新型出生前診断を行っています。患者に寄り添う姿勢を大切にし、先進医療を提供...
-
- うつ病に宮城のクリニックがおすすめです
-
人間だれしも、どのような人も気分が落ち込むことがあります。毎日明るく前向きでポジティブシンキングな人も、塩とで失敗したり失恋したり...

-
- インビザラインが可能な川越の歯科
-
埼玉県にある川越ホワイト歯科クリニックは、日曜祝日以外の毎日診療を行っている人気の歯医者です。東武東上線の川越駅から歩いてすぐの場...
-
- 仙台で安心してAGA治療を始めるなら
-
AGAは多くの男性の悩みですが、現代では様々な治療方法が登場しており悩みを克服できる人も増えてきました。自毛植毛などの高度な治療も...
-
- 渋谷のセラミック治療ならここを選ぶ
-
渋谷のセラミック治療なら、Tokyo-Ite Dental Clinicがおすすめです。このクリニックは最新の技術を駆使し、患者様...
-
- 名東区の口腔外科でインプラントを
-
この技術は1960年代にスウェーデンのPer-IngvarBr?nemark博士に、よって発明され以来歯科医療における歯の欠損施術...

-
- 五反田で効果的な歯周病の治療ができる
-
歯の病気の中でも最も怖いのが歯周病と言われており、これは単に歯だけではなく体全体に大きな影響を及ぼしてしまうことから注意をしなけれ...
-
- 豊平区で胃カメラ検査を見つける手順
-
昔に比べてインターネットのサービスが、豊平区でかなり充実するようになってきたと言うことが言えます。スマホやタブレットなどのデバイス...
-
- 白井市の歯科をしっかりと選ぶポイント
-
白井市のファミリー歯科にししろいでそのため定期的に、クリニックを訪れメンテナンスを行うことが肝要です。次に矯正措置を行うこと、もで...

-
- 高度な技術で対応する小山市のクリニック
-
小山市で営業をするこの歯科クリニックでは、審美歯科やインプラント、矯正歯科などを担当しており、熟練の技術力を持つ医者の他、最先端医...

-
- 世田谷区で人気のリフトアップ治療
-
たるみやシワを防ぐためには、マッサージや顔の筋肉を鍛えるエクササイズも効果的です。努力を続けることでより長く若々しさを維持すること...
-
- 自然な見た目の医療用ウィッグの通販
-
この医療用ウィッグの専門店は、ナチュラルな見た目のかつらの販売やレンタルをしています。一見しただけではかつらだと気づかれないことも...

-
- 清水区で評判の高い矯正歯科医院
-
歯科医院は全国に実に多く存在しますが、矯正治療は長期に及ぶことになりますので失敗のないよう慎重に選ぶ必要があります。清水区で矯正歯...
-
- 八幡西区で健診可能!精密検査も対応
-
よしの胃腸内科クリニックでは、八幡西区内で計4件しかない特定検診認定クリニックとなっています。この検診は2000年から厚生労働省に...
-
- 大島駅前の地域密着型の歯医者の概要
-
大島駅前にあって気軽に診察を受けられるのが、おおじま駅前歯科・大島駅前矯正歯科の特徴です。地域に密着した歯医者なので、近隣の人たち...
-
- 下肢静脈瘤治療で評判の埼玉のクリニック
-
東京や埼玉にお住まいで、下肢静脈瘤にお悩みの方にお勧めしたいのが、草加市にあるメディカルトピア草加病院です。この病院ではレーザー手...

-
- 東海市で訪問歯科を利用する事ができる
-
歯のトラブルなどがある場合は歯医者にいって治療を行う必要がありますが、多くの人がだれでも来院できるというわけではないという点があり...

-
- 豊平区で内視鏡検査をする前の注意点
-
通販サイトなどでも購入できないものはないといっても、豊平区でいいほど数多く6のが購入できるような時代になりましたし、動画や音楽など...
-
- 奈良市の歯医者で受けるホワイトニング
-
奈良市にある「たかだ歯科医院」は、虫歯や歯周病など一般的な治療の他に審美歯科治療も行っている歯医者さんです。この歯医者さんで受けら...

-
- 後期中絶についても詳しいクリニック
-
東京都豊島区のJR山手線沿線にある山手大塚レディスクリニックは、北大塚の大塚駅より徒歩0分というアクセス良好な好立地に位置します。...

-
- 伊勢市で信頼できる矯正歯科をお探しなら
-
伊勢市でも多くの歯科医院がありますが、矯正のように長期に続ける治療の場合は長期間でも無理なく通えることが大切です。それゆえ、近隣で...

-
- 手稲区のオススメ小児科・アレルギー科
-
アレルギーを起こす原因物質のアレルゲンは年齢によって変化します。特に乳幼児は消化吸収能力等の機能が未発達なため、食物アレルギーや気...
-
- 大和市の歯医者によって技術力が異なる
-
街中に歯科がかなり多くなってきた、というような印象を大和市で持つことのないでしょうか。確かに以前であれば、それほど街中になかったよ...

-
- 大村市でマウスピース矯正を受けられる
-
歯並びが悪くなると審美性だけではなく、噛み合わせに問題が生じて食事や会話の際に問題が生じる場合があります。そのため、歯の矯正を行う...

-
- 春日部市で歯の治療を行っている
-
歯並びや?み合わせに関して不安を感じている場合にはできるだけ早く歯科医院に行って診てもらう必要がありますが、どこに行けば良いのか分...

-
- ICL手術にも対応する島田市の眼科医院
-
静岡県島田市金谷扇町にあるこの眼科医院では、ICLとよばれる手法による眼の治療を受けられます。ICLは日本語では眼内コンタクトレン...

-
- 東海市で安心して通える小児歯科
-
子どもの歯は大人よりも弱いこともあり、油断しているとすぐ虫歯になってしまいます。それに、子どもは歯みがきが十分にできていないことも...

-
- 内科小児科のある大林町の井上医院
-
家族でかかりつけのお医者さんがあると安心です。何かあったときにすぐに相談することが出来ますし、急な熱でも慌てる事はありません。最初...

-
- 郡山市でお客さんに評判の歯科を
-
郡山市で、地域の人に評判になっているのが南山歯科医院です。レーザー治療を取り入れ、痛みや不安を減らすことができているのが話題です。...
-
- 埼玉でスポーツ整形外科をお探しなら
-
埼玉にあるこちらの病院の一般外来では、様々な診療科目が取り扱われています。総合内科や皮膚科の他、整形外科にも対応していますので、ス...

-
- 大田区で歯科医の利用が増えている
-
大田区で歯科医を利用する方が増えています。食生活に偏りが見られたり食後の歯磨きに問題があったりすると、知らぬ間に虫歯を発症すること...

-
- 人工中絶手術を東京で受ける方に
-
事情があって赤ちゃんを産むことができない方は、人工中絶手術を選ぶことになりますが東京で良い病院を選ぶなら山手大塚レディスクリニック...

-
- 飯田市でホワイトニングも可能な歯医者
-
白い歯を目指したいけれど、市販されているホワイトニング歯磨き粉ではあまり効果が無かったという方はいませんか。市販されているそういっ...

-
- 天神ホワイト歯科とインプラント
-
歯のトラブルに悩む方は多いですが、歯周病などで抜けてしまった歯をどう処置していくかを考えたときに、入れ歯などの選択肢がある中で、イ...

-
- 松山市でホワイトニングによる虫歯予防
-
松山市にあるこちらの歯科医院では、矯正歯科と歯周病治療を主軸に舌・呼吸・姿勢のトレーニングといった多彩なプログラムや診療体制を整え...
-
- 札幌市で婦人科クリニックのおすすめは
-
札幌市で子宮筋腫の疑いや子宮頸がんの検査をしたいと婦人科を探している方は、産婦人科を探してみると一緒に見てくれることがほとんどです...
-
- 高津区で地域のホームドクターに相談
-
国島医院は、高津区で内科や小児科などの診療を行っている地域のホームドクターです。循環器や呼吸器に関連する病気も取り扱い、地元住民の...

-
- 安佐南区で治療先を選定する重要性
-
歯科で本当に満足のいく治療を受けようと考えるのであれば、安佐南区で丁寧にそのような下調べを進めていくと言う事は、忘れないように心掛...

-
- 北九州で精神科を探すならここで
-
今は多くの方が職場や学校や家庭で様々なストレスを抱えています。少しぐらいのストレスであれば、十分な休養と美味しい食事や気分転換をし...
-
- 目黒区で一押しの小児矯正クリニック
-
お子さんの時から歯並びの事を考えてあげるということは、将来的にもメリットが大きくなりますしコンプレックスを一つ減らしてあげることに...

-
- 都筑区にあるおすすめの婦人科について
-
つづきレディスクリニックは、横浜市都筑区にある婦人科です。その診療内容は多岐にわたります。一般婦人科をはじめ子宮がん検診や妊婦健診...

-
- 釧路市民に選ばれている歯医者さん
-
釧路市にある「よしもと歯科・矯正」は、1981年の開院以来多くの患者さんに選ばれています。選ばれている理由の1つに挙げられるのが、...

-
- インプラント治療で有名な堺市の歯科
-
インプラント治療ではあごの骨を削ったり、金属の土台を埋め込むなどの手術を行います。通常の歯科治療とは違い、時間もかかりますので、信...

-
- 浜松市で注目の歯並び矯正可能な歯科
-
浜松市エリアにも、歯科クリニックは多数存在します。基本的には虫歯や歯周病の治療を行うというのがメインではありますが、今審美歯科にも...

-
- 小牧市の内科に色々と相談しよう
-
小牧市の内科に依頼出来ることは実に多いです。例えば、ちょっとした風邪であってもこじらせると大変ですから、まずは相談に行ってみましょ...
-
- 川越でオススメできる、矯正歯科
-
「川越ホワイト歯科クリニック」は、東武東上線とJR 川越線の川越駅西口から徒歩1分にあります。提携駐車場もあるので、車でも通院でき...
-
- 飯田市でインプラント治療を行うには
-
私たちにとって歯は大変大切なものです。一見私たちの健康と歯とは関係ないように思えますが、実は大変深い関係があります。なぜならば、私...

-
- ICL治療を受けるならここがおすすめ
-
静岡県島田市にある『金谷眼科』は「患者の幸せに貢献し、最良の医療とホスピタリティの提供」をモットーに、小さな子供から年配の方まで、...

-
- 東京にある顎関節症のプロフェッショナル
-
東京にあるこの歯科は顎関節症の知見がたくさん持っているクリニックです。顎関節症には後方にズレたあごの関節円板の位置を正しく把握して...
-
- 信頼の矯正の歯医者を仙台市で見つける
-
矯正治療をすると言うと昔は小学生や中学生といった子どもが相場でしたが、仙台市内で最近はその平均年齢が非常に上がってきている傾向があ...
-
- 山形市より全国に泌尿器の情報も発信
-
株式会社山形コミュニティ新聞社は市内に本社を置いている会社で、地域密着型フリーペーパーの「やまコミ」を発行しています。フリーペーパ...

-
- 歯周病の治療をする藤沢市の歯科
-
藤沢市にある歯科クリニックで、JR藤沢駅から徒歩3分程の距離にあります。診療時間は9時から12時30分、14時から19時30分、休...

-
- 西武池袋線沿線で矯正歯科に行くなら
-
歯並びがよくないので、歯列矯正したいと思っていませんか。子供であっても大人であっても歯並びが悪いのであれば、それは治した方が良いで...

-
- 東京都内でおすすめの婦人科クリニック
-
生理周期が毎月バラバラで脱毛サロンの予約をしたり旅行の計画を立てたりするのに苦労する、生理休暇を取得できるルールはあるけど職場の人...

-
- 池袋で歯の治療なら駅近くの歯科
-
池袋で虫歯や親知らずの治療を受けたい、ホワイトニングや矯正をして歯を綺麗にしたい、病気の予防をしたいと考えているなら駅近くの歯科で...

-
- 柏市のインプラント治療について
-
インプラント治療という言葉をよく耳にされるかもしれません。この治療法とは人工歯根を顎の骨に植え付けて、噛む力が従来と同じような感じ...
-
- 四条烏丸エリアで評判の高い矯正歯科
-
四条烏丸の「あおい矯正歯科」は、30年以上の歴史を誇る歯列矯正専門の歯科医院で、幼児から高齢の方まであらゆる世代の歯並び治療に対応...

-
- 天神にあるおすすめの歯科クリニック
-
福岡市中央区天神にある本歯科クリニックでは、歯科治療技術が日々進歩している。その事実と真摯に向き合っています。そのため、本歯科クリ...
-
- 様々な治療を扱う大村市の歯科医院
-
大村市にあるこちらの歯科医院では、虫歯治療から美容診療、セラミック治療まで様々な診療科目が取り扱われています。虫歯治療では歯の保存...

-
- 伊丹市にある目立たない矯正ができる歯科
-
伊丹市にある歯科医院では、マウスピース矯正とも言われるインビザラインを導入しています。この方法は世界で最も行われている方法であり、...

-
- 名古屋市緑区のこじまデンタルクリニック
-
名古屋市緑区の歯科医院、こじまデンタルクリニックは乳児から高齢者までのお口の健康をサポートしています。歯には健康的な生活を送るため...

-
- 丁寧な診療を実施する日本橋の皮膚科
-
現状悩んでいる皮膚トラブルを少しずつ解消できるように丁寧な診療や治療を行っており、たくさんの患者が通院している日本橋の皮膚科です。...
-
- 西大寺にある専門治療を行う歯科
-
奈良県の金鉄西大寺駅近くで、1998年に開業した「西大寺こじか歯科診療所」では最新の歯科治療を実施しているクリニックです。昨今では...
-
- 石川県金沢市の眼科クリニックを受診
-
おおくぼ眼科クリニックは、最善の医療を目指して適切な治療を提供している金沢市の医療機関です。初診の場合は予約が不要で、土曜日の午前...
-
- 名取市から通いやすい矯正歯科クリニック
-
いわぬま矯正歯科クリニックは宮城県岩沼市にあります。最寄り駅は東北本線の通る岩沼駅であるいて10分の距離です。名取市との協会とも近...
-
- 渋谷の矯正歯科でよいとこを見つけよう
-
昔に比べて大人で矯正治療をしたい、という人が渋谷でかなり多くなってきている傾向があるのはご存知でしょうか。子供で矯正治療をしたいと...

-
- 早良区でインプラントをしたいならば
-
本当に心から満足のいくインプラント治療をするためには、どういったことが大切なんでしょうか。最近はインプラト治療をしたいという相談が...

-
- 豊中市で整骨院を探しているなら
-
首・肩・腕・腰・膝などの痛みや、捻挫・打撲・骨折・脱臼などの症状を改善するために整骨院に通うことを検討しているものの、どこに通院す...

-
- 南橋本の歯科クリニックで適切な治療
-
飯豊歯科クリニックは、JR相模線の南橋本駅から歩いて1分の場所にある医療機関です。子供から大人まで全ての患者の悩みを丁寧に聞き取り...
-
- 新宿で実績のある整体で治療しませんか
-
肩こりや腰痛などで悩んでいる人はとても多いです。慢性的な便秘で悩んでいる人もたくさんいますし、今ではスマホを使うことが多くなったの...
-
- 今治市の大人が矯正治療に踏み切る理由
-
矯正治療と言うとどのような人が行ってる、イメージがあるでしょうか。もしかすると小学生くらいの子供が行うというようなイメージを持ちが...
-
- 名古屋市で日帰り口腔外科手術が出来ます
-
名古屋市にあるこちらの歯科医院では、局所麻酔を使用した日帰りの口腔内の外科手術が可能です。外科手術と聞くと多くの方は身構えてしまう...

-
- カスタム型の松山市の矯正治療の魅力
-
矯正治療で不安を抱えている人は、カスタムメイドで作ってくれるマウスピース矯正が良いです。松山市の矯正歯科では、安心して相談できて評...

-
- 日帰りで親知らずを抜ける郡山市の歯科
-
郡山市で診療を行っている「南山歯科医院」は、口腔外科も扱っています。この歯科医院には豊富な知識と確かな技術を備えた先生がいるので、...
-
- 宇都宮市にある矯正専門歯科クリニック
-
歯並びが整っていると見た目に美しいだけではなく、毎日のブラッシングもしやすく磨き残しもなくなるので、虫歯や歯周病予防にもなり、身体...

-
- 豊平区で大腸カメラ検査を受けるなら
-
筋肉痛や神経痛や関節痛や頭痛や発熱やだるさや動悸や不整脈や不眠症や更年期障害やめまいや耳鳴りや虫歯や眼精疲労など、症状があってもほ...
-
- もしかしてコロナ?郵送PCR検査の流れ
-
発熱や咳の症状が出たときは、コロナ感染が疑われます。また、急な出張や楽しみにしていた旅行の前には安全を確認するためにも陰性証明を取...
-
- 小山市で歯医者に通う方が増えている
-
小山市で歯医者に通う方が増えています。日頃の歯磨きの習慣に問題があったり、食生活に偏りが見られたりすると、知らぬ間に虫歯を発症する...

-
- 葛飾区でコロナワクチンが受けられる病院
-
葛飾区にある「医療法人社団いつき会ハートクリニック」は、内科全般や生活習慣病など幅広い診療に対応しているクリニックです。コロナワク...

-
- サージカルマスクの購入ならこちらへ
-
新型コロナウィルスの流行から既に長期間が経過していますが、ウィルスの感染拡大は未だに収束の目処が立っておらず、これからまだしばらく...
-
- 美容皮膚科も利用できるクリニック
-
この皮膚科クリニックは名古屋で開業をしていますが、一般的な皮膚科の他にも美容関連での治療や施術も行っているので、美容関連にトラブル...

-
- 海老名で原因から解決できる歯医者
-
海老名の審美歯科に通いたいなら、K’sデンタルクリニックを選んでみるとよいです。K’sデンタルクリニックでは、虫歯や歯周病の原因か...
-
- 京都での不妊治療ならSR鍼灸烏丸へ
-
不妊治療に取り組む人たちが増えています。晩婚化ということもありますが、男性不妊という問題もクローズアップされてきて、オープンに話せ...
-
- 札幌で良質のプラセンタ注射をするなら
-
札幌市西区にる女性専門のクリニックは、誠実な医療をテーマにして診察と施術を行っているので、良心的な料金で美容と健康の高い効果を期待...
-
- 痛みに配慮してくれる有田川町の歯医者
-
有田川町の「ささの歯科クリニック」では、虫歯や歯周病といった一般歯科をはじめ、小児歯科・予防歯科・矯正治療・審美歯科などの幅広い歯...
-
- 今治市で歯科医選びをする重要性とは
-
最近歯科医院の数が非常に多くなってきている傾向があるのは、あなたもご存知かもしれません。コンビニの数よりも多くなってきている、とい...

-
- 肌のはりを取り戻すなら日本橋形成外科へ
-
東京都中央区にある日本橋形成外科では、できものなどを治療する形成外科や皮膚科とスキンケアの診察を行っています。年齢を重ねるにつれて...

-
- 歯医者さんは世田谷区のこちらがおすすめ
-
歯医者さんを選ぶ時のポイントはその方によって違うかもしれませんが、通いやすい事や信頼できる事などがあげられるでしょう。また専門的な...
.jpg)
-
- 何でも相談できる岩国市の歯医者さん
-
歯は人間にとって非常に重要なパーツです。歯が命を司っていると言っても過言ではありません。歯が健康で咀嚼が正常でなければ食事を頂くこ...

-
- 金沢市で実績のあるあおば歯科クリニック
-
歯の治療は、忙しかったりすると中々腰をあげるのが億劫だったりしないでしょうか。ですが歯は放っておくと虫歯が悪化したり歯の病気にかか...

-
- 田町駅からも通えるレディースクリニック
-
こちらはレディースクリニックで、田町駅からも近くて通いやすいところにあります。アクセスが便利だと、面倒な通院の負担が軽くなるので便...

-
- アトピーの治療ができる麹町の内科
-
東京都千代田区麹町ある内科で、地下鉄半蔵門線の半蔵門駅3a出口からすぐの所にあります。診療時間は10時から13時、15時から19時...

-
- 長岡市の特選歯科を紹介させて頂きます
-
家族皆で安心して通院できる歯科医院を目指す、みずほ歯科口腔外科は小児及び虫歯予防を含む一般歯科並び歯周治療の他口腔外科診療を行って...
-
- 6歳頃には藤沢市の歯科で歯並びの検査を
-
藤沢歯ならび矯正歯科は、藤沢市で矯正治療を専門に行っているクリニックです。日本矯正歯科学会の認定資格を取得しており、矯正治療に関し...

-
- 荒井エリアでお勧めの歯医者さんです
-
荒井エリアにお住まいの方で、かかりつけの歯医者さんをお探しでしたら田沼七郷歯科クリニックをお勧めします。一般歯科と口腔外科、小児歯...

-
- 高槻の歯周病などをみてくれるクリニック
-
歯は人にとって非常に大事なパーツであることは言うまでもありません。歯を用いて租借し、食べ物を食堂に送り込むので歯が健康でなければ命...
-
- 福島市でインプラント治療ができる歯医者
-
この歯科医院は昭和20年4月に福島市飯坂で開業しています。患者ファーストをスローガンに、日々業務に取り組んでいます。診療時間は平日...
-
- 矯正歯科のサイトをチェックして選ぼう
-
歯並びを治すと言うと、小学生、子供が行うことのイメージが強いですが、最近では大人の人たちからも大変注目されている治療法です。という...
-
- 椎名町で注目されている歯科治療とは
-
以前に比べてインプラント治療したいと考える人が、椎名町でかなり多くなってきている傾向があるのはご存知でしょうか。どこの歯科医院でも...
-
- 天王寺でインプラント治療を受けるなら
-
インプラント治療に興味がある方は、大阪市にも数多くいらっしゃるかと思います。しかし、日本には数多くの歯科医院があり、その数はコンビ...
-
- 安全性と信頼性で選ぶ大和市の小児矯正
-
転んだ時に前歯をぶつけてしまったり、虫歯の症状が悪化する事で歯並びが歪んでしまった時に、大和市の小児矯正で有名な林間矯正歯科が助け...

-
- 訪問診療を行っている三郷市の歯医者
-
吉崎歯科医院は埼玉県三郷市で地域に密着した診療を行っている歯医者で、三郷駅からは徒歩5分でアクセス可能です。日本補綴歯科医学会や日...
-
- 藤沢で信頼できる矯正歯科を見つけよう
-
歯科医院の治療と言うと、どこも同じというような印象を持ちがちではありますが、実際のところはかなり違うということは、押さえておく必要...

-
- 綾瀬の内科は土曜日の診療を行っています
-
寒い時期になると風邪やインフルエンザなどの、感染症に罹りやすくなります。くしゃみや咳、発熱、関節の痛みなどが見られる場合は、なるべ...
-
- 【松戸市】無痛分娩を検討中ですか
-
松戸市で出産のご予定で、すでに分娩方法は決めましたか。「出産をしたいけど痛いのは苦手」という人にとって、【無痛分娩】はとても気にな...

-
- 芦屋市で信頼のおけるインプラント
-
大人の永久歯は子どもとは違って自然に生え変わることがありませんので、一生の宝としてたいせつにしなければなりません。しかし虫歯などを...
-
- 札幌でインプラントをしたいならば
-
インプラント治療はどこで受けても、札幌で同じになるのではないかというふうに考えてはいないでしょうか。確かに一見するとどの歯科医院で...
-
- 世田谷区にある歯科医院はとても多様
-
小学生くらいの子供であれば昔からよくあった矯正治療ですが、最近は大人でも依頼する人がかなり増えてきている傾向が世田谷区であるのはご...
-
- 函館市で矯正歯科を探しているなら
-
歯並びが気になる、歯がぐらつくといった悩みを抱えているのであれば、すぐにでも専門家の診察が必要です。函館市にある「函館こんの歯科・...
-
- 松山市で歯並び矯正が可能な歯科
-
大谷歯科矯正歯科は、松山市で歯並び矯正を行うことが出来る歯科になります。歯並びが悪いと歯にとって様々なリスクがあり、歯磨きがとても...
.jpg)
-
- 4つのこだわりがある日本橋の皮膚科
-
こちらの皮膚科と美容外科のある日本橋形成外科には、4つのこだわりがあります。近年は医療機関でも院内感染も増え大きな問題となっていま...
-
- 住之江区などの施設を紹介するサイト
-
住之江区をはじめとした様々な老人ホームの情報を紹介しているのは、社会福祉法人帝塚山福祉会のホームページです。各地の老人ホームなど情...
-
- クリニックで大学病院レベルの医療を提供
-
国島医院は、神奈川県川崎市高津区に50年以上前から開院している医療機関で、内科・循環器科の専門医の診察・治療が受けられます。専門分...

-
- ストレスを感じない福岡市の矯正歯科
-
福岡市で仕事を行っている、この矯正歯科は高級感と清潔感が感じられる空間に仕上げています。歯並びについて何らかの心配やコンプレックス...

-
- 高知で訪問も可能な地域密着の皮膚科
-
高知エリアにも皮膚科は色々ありますが、地域密着型で来院できない方への訪問も可能なところといえばあさひ皮フ科です。経験も豊富な医師は...
-
- 大腸検査を行える名古屋のクリニック
-
大腸の状態は便の様子によってある程度知ることができます。ですが実際のところ大腸から出血が起きている場合は病気が進行している可能性が...
-
- 高松市の歯医者は子供や高齢者におすすめ
-
突然歯が痛くなったり、詰め物が取れてしまい困った経験のある人が少なくありません。子供がいるご家庭では、親子で通院をしている人が増え...

-
- 宮古島の内科で予防接種を受けよう
-
沖縄県宮古島には、病気になった場合の相談先や生活習慣病改善のために、通院出来る病院があります。それが「中島胃腸科内科」です。院長は...

-
- 初心者におすすめなマウスピース矯正
-
矯正歯科という言葉を聞いたことはありますか。矯正歯科というのは歯並びを器具を使って調整することで、ガタガタの状態ではなくきれいな状...

-
- 精密で速い仕事を行う座間市の矯正歯科
-
座間市で営業している、この矯正歯科は矯正専門としているので実績が非常に多いという特徴があります。これまでに培ったノウハウと経験の他...
-
- 高い専門性が必要な神経眼科診療を実施
-
金沢市の眼科として地元の人々に親しまれているおおくぼ眼科クリニックは、金沢市小坂町のJR金沢駅から近い場所にあります。あらゆる眼疾...

-
- 地域の健康サービスステーションです
-
いつき会ハートクリニックは、実際に小学生時に心臓病で手術を受けた経験を持つ院長が運営しているクリニックであり、2009年の開業以来...

-
- 赤ちゃんが鍼灸で授かるについて
-
不妊に悩むカップルは年々増加しています。原因としては、結婚の時期が遅くなっていることや妊娠を望む時期が遅くなっていることが多いです...
-
- ストレスなく通える歯医者の見つけ方
-
歯の健康は決して口の中だけの問題ではありません。歯は身体全体にも影響を及ぼしているのであり、肩こりなどといった腰痛があるといった問...
-
- 白内障のリスクは加齢と共に高くなる
-
年齢を重ねるにつれて視力の低下が進行していきますが、その主な原因として白内障が挙げられています。長い年月を経て蓄積された眼球の角膜...

-
- 寝屋川で救急の患者に対応する診療所
-
大阪府枚方市にある長尾台診療所の内科・小児科・胃腸科は、平日だけでなく日曜と祝日にも診療を行っています。診療時間は診療内容によって...

-
- 伊賀市で子供が安心して通える歯医者
-
子どもの歯は大人に比べて弱いこともあり、しっかりと歯磨きをしているつもりでも虫歯になりやすい傾向にあります。虫歯はできるだけ早く治...
-
- 目立つすきっ歯を治したい方はこちら
-
日常生活のおしゃべりや仕事の会議など、人と話す機会は尽きません。そんな中で、歯を見せる事も増えてきます。きちんと生え揃ったものなら...
-
- ナチュラルさが魅力の医療かつら
-
こちらのサイトでは、ナチュラルな仕上がりが魅力の医療かつらを多数取り扱っています。流行のヘアスタイルを取り入れたものも数多く揃って...

-
- 審美性を兼ね備えた歯列矯正治療
-
浜松市にある「いとう歯科矯正歯科ティースエクセレントクリニック」は、歯並び矯正を得意としている歯医者さんです。浜松市やその周辺には...
-
- 信頼性の高い胃内視鏡検査のクリニック
-
胃内視鏡検査を受けることをお考えの方は、多くいらっしゃるものです。しかし検査の詳細についてしっかりと把握されている方は少ないため、...

-
- 透析が必要になった時に頼れる医療機関
-
医学が飛躍的に進歩した結果、以前では助からなかった命も、様々な治療を通して生活レベルを落とさずに日常生活を送ることができるようにな...

-
- 枚方市にあるかかりつけ医に最適な病院
-
枚方市内にはたくさんのクリニックがありますが、その中からかかりつけ医を選びたいなら大谷ハートクリニックを選んでみてはいかがでしょう...

-
- 安全な検査をしている福住内科クリニック
-
大腸カメラの検査をするなら豊平区にある福住内科クリニックがおすすめです。福住内科クリニックは、平日は19時30分まで診療しており、...

-
- 郡山市でホワイトニングをするなら
-
福島県郡山市にある「南山歯科医院」は、地域に根ざし、30年以上の実績と技術によって歯に関する治療すべてに対応しています。口腔内のこ...

-
- 技術や医療機器が進化している白内障手術
-
白内障を治療する手術のレンズや方法は年々技術や医療機器が進化して、精密な施術を行うことが出来るようになり、入院する必要ななく日帰り...

-
- 見えない矯正をするならあおいに矯正歯科
-
京都市下京区にある、あおい矯正歯科は見えない矯正を得意としています。裏側矯正というのもので、歯の裏側に矯正装置を装着し、治療すると...
-
- 「アイリスデンタルクリニック」のご紹介
-
防府市西浦にある「アイリスデンタルクリニック」は虫歯・入れ歯治療をはじめインプラント治療や顎関節症治療・口腔がん検診に至るまで、口...

-
- 安心して通うことができる歯科クリニック
-
宇都宮にあるりょう矯正歯科クリニックでは、歯の矯正治療が行われています。矯正治療をおこなえば歯並びの問題を解決することができるため...
-
- 秦野市の歯科医院による歯周病治療の内容
-
神奈川県秦野市のかわしま歯科医院は、「人として人と接する」という事をコンセプトに歯科治療を提供しているクリニックです。円滑なコミュ...
-
- キャリアアップ可能な介護職員の求人
-
天王寺にあるこちらの介護施設では、高齢者施設で入所者の生活サポートを行う介護職員を募集しています。具体的な仕事内容は入所者の生活サ...

-
- 歯の矯正は精密な治療が可能な歯医者で
-
小さな子供から高齢者まで通える、技術力の高い宝塚の歯医者がおすすめです。歯の矯正に豊富な実績があり、安全で確実性の高い方法で歯並び...

-
- インプラント治療を行っている柏の医院
-
自然な歯と近い機能を再現できるとして注目を集めているインプラントですが、具体的なことがわからず治療を受けるかどうか迷っている、とい...

-
- 清水区の小児歯科で口腔の健康を
-
歯科に本格的に行くのは大人になってからでも問題ないという声がありますが、子ども時代から行くことに意味があります。子ども時代に歯科嫌...
-
- 福岡市で実績の豊富な歯医者を探すなら
-
歯の治療の際には、歯医者に向かうことになりますが家から近いからなどで安易に選ぶ人も少なくありません。新しいクリニックは続々と登場し...

-
- 白内障を島田市で素早く改善しましょう
-
目元のトラブルにはいろんな種類があります。飛蚊症やドライアイなどが定番ですが、とりわけ厄介なのは白内障・緑内障になります。いずれも...

-
- 大腸内視鏡検査実績1万件超で信頼できる
-
横浜市営地下鉄「関内」駅の9番出口から歩いておよそ4分で到着できる場所に、大腸検査を実施している粉川クリニックがあります。こちらの...
-
- 審美性のあるインプラント治療ができる
-
福岡市の永嶌歯科クリニックでは、通常の歯科治療を行ってもらえるうえに審美性を考慮した最新鋭の治療も実施してくれるメリットがあります...

-
- 不育症かもしれないと感じる時は受診を
-
性行為を行なえば、女性は誰でも妊娠出産することが出来ると考えていた人は多いのではないでしょうか。世の中の多くの夫婦が子どもを儲けて...
-
- 福岡市中央区で歯医者さん選びをするなら
-
歯の黒ずみや黄ばみが気になり歯を見せて笑うことに抵抗感がある、歯並びの悪さにコンプレックスを感じている、インプラント治療をしたいけ...
-
- 堺市でのインプラント治療について
-
堺市にてインプラント治療、審美歯科、神経や歯周病の治療などを行っています。インプラント手術を行う際には、高度な感染対策を施した環境...

-
- インプラント治療実績の高い中央区の歯科
-
虫歯や歯周病で抜歯をして歯を失ったときには、そのまま放置していると歯並びが変化してしまうなど、悪影響が考えられます。そのために失っ...

-
- 名古屋にお住いで不妊に悩みがある時は
-
病気になると頼りになるのが病院です。どこの病院でも同じ治療が受けられるかと言えばそうではなくて、もちろん内科や外科などで違いはあり...

-
- 無痛で胃カメラ検査を行っています
-
現代では、二人に一人はがんにかかる時代だと言われています。そのためがん検診を受けることが推奨されていますが、毎年検診を受けている人...

-
- 磁性アタッチメント義歯と健康寿命
-
歯科の技術は日進月歩、次々に新しい技術が導入されています。その中でも最新の歯科治療として注目されているのが、磁性アタッチメントとい...

-
- 爪白癬の治療は初期対策が肝心です
-
ふと、足の爪を見てみると、痛みもかゆみもないのに白く濁っているなどの変化が出ている、それは爪白癬かもしれません。通常の水虫などと違...

-
- 守山区のクリニックでインプラント治療
-
ききょう歯科クリニックは、愛知県名古屋市守山区にある人気クリニックです。診療科目が幅広く、新しい治療法にも力を入れています。歯周病...
-
- ツムラの漢方と芍薬甘草湯について
-
日本で漢方薬の会社といえばツムラが有名です。創業1893年、業界シェアは実に80%以上を誇り、売り上げは1,178億円あまりに達し...

-
- 心療内科でカウンセリングを受ける
-
先進国の中でもストレスが多い国として有名な日本ですが、最近は精神の問題を抱える若者が増えています。精神の問題を他人に相談できないと...
-
- 子供の歯を矯正するための歯科医院選び
-
三軒茶屋矯正歯科クリニックは世田谷区で開業している矯正治療専門の歯科医院です。特に子供を対象にした小児矯正については、柔らかく刺激...

-
- 横浜で内視鏡検査なら粉川クリニック
-
粉川クリニックは横浜にある内科・消化器科・内視鏡検査を行っているクリニックで、休診日は水曜日・日曜日・祝日です。診療時間は外来と検...

-
- 沼津インプラントの治療が可能な歯科医院
-
沼津インプラントの治療が出来る、歯科医院になります。患者様が主役の歯科治療をモットーに、患者様一人一人の状態に合わせ、ご希望に応え...

-
- 安心できる治療と通いやすさのなかの歯科
-
インプラントを入れたいので安心できる歯医者さんを探している方は、三重県伊勢市のなかの歯科を検討してみるとよいかもしれません。インプ...
-
- 兵庫県西宮市にあるなかた内科クリニック
-
兵庫県西宮市にあるこのクリニックは2012年12月に開業しており、ほぼすべての領域の内科疾患を診察してくれます。その中でも特に専門...

-
- 生活習慣病の診療を行っています
-
小牧市北外山にある小牧クリニックは、平成元年に人工透析専門クリニックとして開院したクリニックです。腎不全の患者は、定期的に人工透析...
-
- 小陰唇手術なら日本橋形成外科へ
-
肥大してしまった小陰唇の治療を行いたい時には日本橋形成外科を利用するのがおすすめです。ここの手術の特徴は、モノフィラメントの吸収糸...
-
- 歯周病の治療も行っている歯科医院
-
歯周病は年齢とともに増えていく症状ですが、自覚症状があまりなく、気が付いた時には進行し歯がぐらぐらしたり、最悪の場合は抜けてしまっ...

-
- 内視鏡設備のある広島市南区の診療所
-
健康診断で胃や腸の要検査だといわれても、内視鏡設備のある大きな病院はかかるだけでも予約が必要でなかなか大変です。開業医であっても内...

-
- 信頼性が高い豊田市の内科について
-
風邪を引いてしまった時に真っ先に足を運ぶのは内科ではないでしょうか。他にも頭痛や腹痛、原因が分からない身体の不調が起こった場合も内...
-
- 神奈川で介護求人に特化した人材派遣なら
-
神奈川で介護求人を探しているなら、株式会社ネオキャリアが運営する「ナイス!介護」がおすすめです。こちらはネオキャリアの介護職に特化...

-
- 名取市で定評のある矯正歯科です
-
歯並びが綺麗だと様々なメリットが発生します。綺麗な歯並びだと口を開けて話すことに抵抗がないので表情が豊かに話したり笑ったりすること...

-
- 男性不妊治療なら烏丸のSR鍼灸 烏丸へ
-
これまでは不妊症は女性の問題と考えられて、治療も女性だけに施され、鍼灸院でも女性の不妊症に対する施術が広く行われています。しかし、...
-
- 長時間透析は病院以外でも出来す。
-
透析は病院以外で出来ないものだと思っている方は多いと思うのですが、医療法人社団Oasis Medicalでは長時間透析だけではなく...

-
- 男性不妊の対応ができる京都の鍼灸院
-
京都市中京区にあるSR鍼灸烏丸では鍼灸による不妊治療を提供しています。施設は最寄りから徒歩5分程度とアクセスが良い場所にあり、和モ...
-
- 金沢市で眼科を利用したい人におすすめ
-
おおくぼ眼科クリニックは金沢市にある眼科で最新の知識と機器を使い治療を行ってくれます。専門なので緑内障や神経眼科、ドライアイやコン...
-
- 磁性アタッチメントで快適な生活を
-
磁性アタッチメントとは、部分入れ歯の一種で、残っている自分の歯の所に磁性がある金属を埋め込んで、入れ歯側に磁石を入れてその力で入れ...

-
- 不眠症や禁煙の相談なら立町クリニックへ
-
現代人は何かとストレスにさらされることが多く、それによって心身の健康を損なってしまうことがあります。最近なんだか眠りが浅くなってし...

-
- 小牧市の信頼できる糖尿病専門医
-
糖尿病は定期健診で発見されることが多い事実からも明らかなように、初期には血液検査で血糖値が高いだけで、他には特徴的な症状もないため...
-
- 脂肪吸引をするとどうなるかを知る
-
足が太いので細くしたいと思っていませんか。二の腕が振袖のような状態で恥ずかしい人もいます。顔の脂肪を減らせないかと真剣に悩んでいる...
-
- インプラントが評判の大分の歯科医
-
インプラントは歯を顎の骨で固定するため、非常に強い力で硬いものを噛んでもしっかりと噛むことができる非常に優れたものですが、顎の骨を...
.jpg)
-
- 実績がある人工透析のクリニック
-
健康診断や血液検査で腎臓に異常があると判断された日地尾は、小牧市の内科クリニックで診てもらうのが良いです。腎臓病に力を入れているク...

-
- 自転車通勤保険があれば通勤も安心
-
電車で仕事に向かおうとすれば、朝の通勤ラッシュに悩まされるようになりますのでストレスになります。無駄に朝からイライラしなくてもすむ...

-
- 新潟市の安心できる肛門専門の医院
-
松波クリニックは新潟市で開業している肛門専門の医院です。外科・内科を診療科目として、患者さんのおしりの悩みの治療を行っています。肛...

-
- 枚方市で有名な循環器内科はここにある
-
「香里ヶ丘ハートクリニック」は枚方市に施設を構えている病院であり、循環器内科がある所として有名であります。ここには経験豊富な医師が...

-
- 名古屋市で婦人科健診を受けるなら
-
女性にとってかかりつけの産婦人科を持っておくことは、健康を維持する為に重要なことです。定期的な健診を受けることで女性特有の病気の予...
-
- 充実した設備で出産できる施設です
-
千葉県の鎌ケ谷市で活動するこのクリニックは産科と婦人科があり、妊娠のサポートをしてくれます。施設内は充実しており、サイト内では内部...
-
- 子供の視力相談を島田市でするなら
-
子供の頃からかかりつけの病院を持つことは、健康維持には重要なことです。子供の視力相談を島田市内でしたいと考える人に、紹介するのが金...

-
- 名古屋市で不妊治療が受けられる病院です
-
ライフスタイルの多様化している近年、結婚後の夫婦関係も家庭に応じて様々です。そのため、子供を望まない夫婦がいても不思議ではありませ...

-
- 最新機器と高い技術による痛くない治療
-
藤沢市内で質の高い歯科医療を望むなら、「ともき歯科クリニック」がよいでしょう。藤沢駅からも近く、通院しやすいのもメリットです。健康...

-
- 金沢市で緑内障治療ならこちらが一番
-
石川県金沢市には眼科クリニックがたくさんありますが、その中でも緑内障の専門医が勤務している眼科は数少ないです。そのような数少ない眼...

-
- 地域に根ざした医療を目指している内科
-
こちらは小牧市の人工透析の専門クリニックとして長い歴史がありますが、糖尿病などの生活習慣病を中心とした内科の外来診療にも力を入れて...

-
- 京都府八幡市付近にて医療機関を探すなら
-
京都府八幡市付近において医療機関を探しているときには、長尾台診療所を訪ねることです。ここは休日診療を行っているので日曜日や祝日も来...

-
- 皮膚科を高知にて探しているなら
-
高知で皮膚科を探しているときには、医療法人旭日会あさひ皮フ科を訪ねることです。ここには今まで大勢の患者さんの診療をしてきた優秀なド...
-
- リウマチで悩む全ての女性に向けて
-
リウマチクラスのホームページをご存知でしょうか。リウマチで悩む全ての女性をサポートするべく立ち上げられており、役立つ情報を発信して...

-
- 桐生市でできる薬物療法のリウマチ治療
-
高齢になるとよく聞く病気にリウマチがありますが、リウマチは身体の免疫に異常が起きて関節に影響を及ぼします。全国にはリウマチに悩む人...

-
- 埼玉県にあるオススメ病院の紹介
-
埼玉県深谷市にある「医療法人良仁会 桜ヶ丘病院」について紹介したいと思います。診察、治療出来る科目は産婦人科、消化器内科、小児科な...

-
- 有名な大阪のクリニックで乳房再建治療
-
乳房再建治療で有名なこの大阪のクリニックのサイトは、乳房を病気や怪我で失ってしまったすべての女性に、自信を持ってお勧めすることがで...
-
- 細胞バンクに関して力を入れている
-
脂肪幹細胞を用いた再生医療が今とても注目されていますが、その内容についてはよく分からない人が沢山います。ただそれにより今まで治すの...

-
- こちらの歯科医院で入れ歯治療をしよう
-
車で通うのに便利な守山区にあるききょう歯科クリニックは入れ歯治療を行っています。こちらの歯医者は、患者さんにしっかりと適合する入れ...

-
- 皮膚に関する悩みを解決する皮膚科
-
関東一円からたくさんの人に利用されている皮膚科があります。ほかの県からの利用も多いクリニックとなっていますが、「福中皮膚科クリニッ...

-
- 矯正歯科医院を栃木でお探しなら
-
この歯科は、栃木県宇都宮市にある、歯の矯正を得意とする歯科です。最寄り駅の宇都宮線宇都宮駅からは徒歩10分であり、バスなら花蔵院前...

-
- 口臭専門外来で行う専門的な検査
-
京都府京都市にある仁科歯科医院は、一般的な治療を行う一般歯科をはじめ、小児歯科、審美歯科、高齢者歯科など幅広い分野で最先端の治療を...
-
- 香里ヶ丘大谷ハ―トクリニックに関して
-
「香里ヶ丘大谷ハ―トクリニック」は枚方市にあり、循環器内科など3の科目に対応するクリニックです。最寄り駅から約5分バスに乗車すると...

-
- 親知らずの抜歯も行うことができる
-
歯科医院では虫歯や歯周病のケア、歯石取り、歯磨き指導といったことを行っていますが、親知らずの抜歯を行わないところもあり、他院にて治...

-
- この歯医者でインプラント治療を受けよう
-
大分県に展開している歯医者で専門的かつ高度なインプラント治療を提供している所といえば、中津市三ノ丁に施設を構える「加来歯科」となっ...

-
- 地元で生活ができる喜びをかみしめて
-
特別養護老人ホームは安い値段で入居ができる老人ホームです。ですがある程度の介護度がなければ入居することは難しくなっています。ですが...

-
- 治療前にしっかりと説明してくれる
-
歯が痛いと美味しい物も食べることができず辛い思いをするので、なるべく早く治すようにした方が良いです。中にはそのうち治ると考えて歯科...

-
- 成城で安心して入れ歯を作ってもらう
-
入れ歯を作るということは、その方にとってはかなり大きな出来事になります。いかに着け心地の良いものを作ってもらうことができるか、いか...
-
- 睡眠の症状に強い自信を持った治療
-
三田のDoctor.Mental shibaは、一般的になっているメンタルクリニックの思想とは異なった思想となっています。心を治す...

-
- レディースクリニックを奈良でお探しなら
-
生理痛がひどい、不順だ、不正出血がある、など女性には女性特有の少々があります。そんな時には婦人科の受診が必要となりますが、奈良の医...
-
- 人の心の安心を処方する調剤薬局
-
名古屋市を中心に愛知県、岐阜県に多数の調剤薬局を展開しているトーカイ薬局は、「ひとの心のいちばん近くに」を合言葉に地域の皆さんの健...
-
- アルコールデイケアなら白峰クリニック
-
近年の若者は、抑制力を失い様々な場所でストレスにかかりやすい状態にあると言われています。子供時代に叱られる事が無かった子供や、ゆと...

-
- 大きな病気の早期発見を心掛けてくれます
-
「多摩メディカルクリニック」は、国分寺で話題の内科です。内視鏡を使った診察で、生命に関わる病気を寄せ付けない環境を作り上げていきま...
-
- 郡山駅から近い歯医者といえばここです
-
福島県郡山市でインプラントの診療を受けたいのであれば郡山駅から徒歩10分の場所に施設を構える「うすい歯科医院」をおすすめします。こ...
-
- 肛門の悩みを解決することができます
-
肛門に痛みや不快感などの悩みを抱えている方は多いですが、デリケートな部分ですので医療機関へかかることをためらう方がいらっしゃいます...

-
- 治験を短期でしてみようと考えるなら
-
治験を短期でしてみようと考えるのならこちらのサイトがあります。治験は治療を兼ねた臨床試験のことです。あくまでもボランティアという立...

-
- 沼田市にある産婦人科の塩崎医院
-
群馬県沼田市にあり、上越線の沼田駅から徒歩五分の立地に構える産婦人科と内科医院、それが塩崎医院です。塩崎医院は昭和27年に開院した...
-
- リハビリを重要視している西田整形外科
-
前橋にある西田整形外科では、リハビリを重要なことだと考えています。リハビリを適切な指導を受けながら行うことによって効果を十分に期待...

-
- 歯周病なら藤沢のクリニックが信頼できます
-
現代では、より健康的な歯を保つために定期健診などに通っている人が、幅広い世代で増えてきています。そのような人々から高い人気を得てい...
-
- 睡眠時無呼吸外来のある枚方市の循環器内科
-
睡眠中に一時的に呼吸が停止する睡眠時無呼吸症候群は、睡眠不足になりやすいため、日常生活に様々な支障を及ぼすことがあります。また、心...

-
- イボのレーザー治療を受けたいのなら
-
老化や病気等の原因によって肌にできることの多いイボは目立ちやすいため、コンプレックスに繋がってしまうことがあります。そうしたコンプ...

-
- 心の重荷を下ろすなら梅田や大阪駅近くの精神科へ
-
精神の不調、心の痛みなどを感じたら精神科へと相談してみるのはいかがでしょう。大阪市北区には福島クリニックという心療内科や神経科を扱...
-
- 埼玉県春日部市で透析治療を行っている病院の情報
-
春日部嬉泉病院附属クリニックは、埼玉県春日部市にある透析治療を行うクリニックです。最寄り駅は春日部駅で、西口から徒歩約2分と非常に...
-
- 歯並びの治療であれば八王子市にあるここがオススメ
-
歯並びのことで悩みを抱えている方はいるかと思います。そのまま放置しておくのもあとあと身体に悪影響を及ぼすことがあります。そのような...

-
- 徳島の訪問看護は丁寧なサポート
-
徳島の訪問看護はリハビリやケアプランを通じて、日常生活に安心して復帰出来るようにサポートを受けることが出来ます。医学に基づいた訓練...

-
- 強い痒みを伴うアトピーの治療は北区の皮膚科がお勧め
-
アトピー性皮膚炎は強い痒みによる湿疹が現れるもので、痒みが良くなったり悪くなったりしながら症状が慢性的に続いていく病気です。この皮...
-
- 精神科の受診経験がある方に良い梅田の医院
-
様々な精神科への通院経験がありながら、症状の改善が見られない方にお勧めの病院があります。心療内科と神経科を掲げてあらゆる症状に対す...

-
- ホワイトニングができる津山市の審美歯科
-
岡山県津山市にある北歯科医院は、低コストでホワイトニング治療ができる審美歯科クリニックです。煙草のヤニや着色汚れがしみついた黄ばみ...

-
- ここはアートメイクの除去も行ってくれます
-
東京に住んでいる女性の中にはアートメイクの除去を検討されている方もいるのではないでしょうか。そんな方たちにオススメするのが、日本橋...
-
- 安価で居心地が良い群馬の有料老人ホーム
-
安価で居心地が良い群馬の有料老人ホームは、入居金や一時金が一切必要ないので、お金の心配がなく入りやすい有料老人ホームです。一昔前は...

-
- かかりつけ医を目指す広島市にある病院
-
日本では予備軍と言われている人まで含めるとかなりの人数がいるとされているのが糖尿病です。生活習慣病とも言われる病気であり、その原因...

-
- インプラント治療に力を入れている堺市の歯科医院
-
医療法人田中歯科は、大阪府...
-
- 専用手術室完備。インプラントのプロフェッショナル
-
入れ歯やブリッジ治療をしていくと、自分の歯がどんどん少なくなっていく。治療しているはずが、噛み合わせが悪い等、ますます問題を抱えて...
-
- 末期がんの治療をする病院について
-
私たちは一生のうちで必ず何かしらの病気になるものです。病気の中には安静にしていれば治るもの、薬を購入して服用すればなおるもの、医師...

-
- 充実したサービスが魅力のインプラント治療
-
低価格・高品質・無料保証付きのインプラント治療を求めるなら、「たかしま歯科」はピッタリの歯科医院です。設定されている料金コースは全...

-
- 輝くような白い歯を手に入れられます
-
人前に出て仕事をする方にとって、歯の白さや歯並びというものは相手に与える印象を大きく左右します。毎日の歯磨きだけでは、どうしても歯...
-
- 東京「八重洲中央歯科」のインプラント治療の紹介
-
東京にある医療法人「八重洲中央歯科」のインプラント治療のご紹介です。この治療方法は、失ってしまって自分の歯の変わりに天然歯根の代用...
-
- 東京でインプラントを受けるなら
-
東京にある八重洲中央歯科という歯科医院では、インプラントや審美歯科、口腔外科、歯周治療、矯正歯科などを取り扱っています。インプラン...

-
- 乳がんのことなら専門医に聞きましょう
-
大阪梅田駅から徒歩1分と好アクセスの場所に乳がん専門医のいる認定施設とされているクリニックがあります。乳がん学会認定乳腺専門医が精...

-
- リラックスして治療できる、とよた歯科クリニック
-
大阪府東大阪市にあるとよた歯科クリニックは、河内小阪駅から徒歩2分のところにあります。「痛い」「怖い」「行きたくない」というこれま...

-
- インプラントが1本15万円でできます。
-
相模原・町田でインプラント治療をお探しならば、たかしま歯科がおすすめです。事故や歯周病で歯を失ってしまうことありますよね。そんなと...

-
- 自由が丘でインプラント治療するなら
-
奥沢駅徒歩2分・自由が丘駅10分の場所にある、たなべ歯科クリニックでは、虫歯/歯周病治療の他に、インプラントや審美歯科・矯正治療の...
-
- 東京でもリワーク支援が受けられる
-
近年では精神的疾患が原因で、社会から一度離れてしまった状態になる人が多く存在しています。ただ、一回でも社会から離脱してしまうと、な...
-
- 矯正歯科などを取り扱っている辻堂駅前の歯科医院
-
こちらの歯科医院は神奈川県の辻堂駅から歩いて1分ととても便利な場所にあります。診療時間は平日9時45分から13時までと14時30分...

-
- スピーディーでクオリティの高いがん検診
-
早期治療が完治に繋がるがんは、いかに早期発見するかが大事です。そんながんを早期発見するための手段として欠かせないのが、定期的ながん...

-
- 千葉で歯を白くしたいならホワイトニングを
-
歯科医院でのホームホワイトニングならご自宅で歯を白くすることが出来ます。黄ばんでしまった歯を白くしたいけど歯科医院に何度も通うので...
-
- 三重県伊賀地区の歯を守る大門歯科医院
-
三重県の伊賀地方は、奈良県の住宅開発とともに発展した地域で、名張市は特にそれらの地域のベッドタウンとしての位置づけを担ってきました...
-
- 10年保証のインプラント手術で安心の食生活を
-
友人や同僚、家族と食事に出かけた時、周囲がどんな料理も美味しく食べている中、一人だけ柔らかい物ばかりを食べているのはみじめなもので...
-
- 有名な歯医者のインプラント治療
-
愛媛で有名な歯医者「松木デンタルクリニック」は、通いやすいということで、多くの患者が訪れます。院内の待合室は、グレープカラーのカー...

-
- 仙台でホワイトニング施術を受けるなら
-
歯科医院で受けることができる施術として、近年日本でも注目が集まっているのがホワイトニング施術です。このホワイトニングを仙台で受ける...
-
- 相模原でむちうちの治療にぴったりの接骨院
-
交通事故に遭った人たちが悩まされる症状として、最も多いものは何なのかと言いますと、むちうち症になります。具体的には、背中や肩、首な...

-
- 胃カメラ・大腸カメラ検査の重要性
-
寝屋川市近くの大阪府枚方市の長尾台診療所では、大病院での検査に匹敵する水準の胃カメラ・大腸カメラ検査が可能です。胃癌・大腸癌は、日...
-
- 福井でインプラント治療ができるクリニック
-
福井県にある小笠原歯科診療所では、むし歯予防の指導や歯周病治療、咬合共生やインプラント治療などをおこなっています。小笠原歯科診療所...

-
- 郡山で歯医者なら、おすすめです。
-
歯周病って以外にも子供でもかかる人が多いのだそうです。大人になるとなおさらです。痛みもなく進行していくので、症状がなくても定期的に...
-
- オルソケラトロジーを受け持っている眼科医
-
オルソケラトロジーの最も優れている点は、元々その人が持っていた視力を元に戻す方法だということです。ライフスタイルによって様々な癖が...
-
- たかしま歯科のインプラント料金
-
インプラントの料金と言えば高いと感じられる方が多くいらっしゃると思いますが、近年では多くの歯科がインプラントを行っている事から手術...
-
- カウンセリングを重視し、設備が整っています
-
インプラント治療などに対応した新潟にあるデンタルクリニックです。診療時間は9時半から19時までなので仕事帰りや時間の都合が良い時に...

-
- 蒲生で交通事故治療するなら白寿堂
-
白寿堂は、埼玉県越谷市の蒲生駅近くで営業をおこなっている鍼療所兼整骨院です。接骨院と整体院も兼ねております。当院では交通事故治療(...
-
- 白衣のホワイトマックス社について
-
白衣のホワイトマックス社という会社があります。ここでは何を取り扱っているのかと申しますと、医療従事者の方が利用するいろいろな白衣関...
-
- 仙台で安心のできるインプラント治療を
-
痛みのない...

-
- 生活習慣病の予防は石原クリニックまで
-
愛知県の岡崎市にある石原クリニックは平成25年3月に新築移転し、これまでより更にくつろげるスペースを確保し高度な医療を提供していま...
-
- 東京駅近くのインプラントを得意とする歯科医院
-
東京でインプラントに通おうという方には、八重洲中央歯科について説明をさせていただきますが、インプラントの治療には特に力を入れている...
-
- 歯のかかりつけならここ、「主侍医」は八重洲中央歯科
-
虫歯の治療だけでなく、口腔のお手入れはライフワークのひとつと言っても過言でないくらい、長期的で継続的なケアを必要としています。東京...
-
- 職場で着用する白衣を通販で購入しています。
-
わたしの職場はユニフォームを各自自由に購入して着用できます。白衣を販売している店舗もありますが、夜勤などもあって日中に自由な時間が...
-
- インビザラインとはマウスピースを用いる歯科矯正です
-
歯科矯正を始めると歯に直接矯正装置を取り付ける事になりますので、口の中に違和感が有ります。食事をしていていも装置が気になってしまい...

